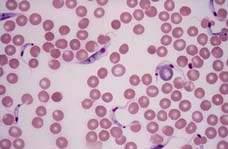

Симбіоз та його форми
Назвіть способи живлення організмів.
Що таке фітофагія, паразитизм, хижацтво?
Міжвидова конкуренція є одним із прикладів взаємозв’язків організмів в екосистемі. Вона зумовлена використанням тих самих ресурсів. Наведемо факти інших форм взаємодії, наприклад у лісі. Росичка заселяє території, на яких росте сфагнум. Такі взаємовідносини зумовлені зміною одним з видів середовища мешкання: сфагнум закисляє ґрунт і робить його сприятливим для росички. Трофічними зв’язками поєднані багато видів: павук живиться комахою, дощовий черв’як – опалим листям, нектар квітки споживає метелик. Часто організми надають притулок іншим, наприклад, дятел робить дупла в сосні.
Науковці в галузі екології пропонують для означення взаємодії між популяціями різних видів користуватися терміном «симбіоз». Симбіозом називають усі форми
Рис. 33. Приклад мутуалізму – співіснування молюска тридакни й водорості
Мушля тридакни може досягати до 2 метрів завдовжки, важити до 200 кілограмів. У тканинах мешкають зооксантелли, які живуть за рахунок фотосинтезу і годують молюска. Молюск перетравлює і частину самих водоростей прямо в тканинах. Краї мантії постійно виступають між стулок мушлі і забезпечені оптичною системою – невеликими світлозаломлювальними конусами, зануреними
живуть у кореневих системах
(горох, квасоля, люпин тощо). Бактерії продукують амоніак, який рослина поглинає й використовує для отримання амінокислот, нуклеїнових кислот, білків та інших біологічних молекул, необхідних для росту й виживання. Рослина забезпечує безпечне середовище й достатню кількість поживних речовини для росту бактерій (рис. 34).
Важливе значення в процесах травлення рослиноїдних тварин мають бактерії, які можуть виробляти фермент целюлазу, що розщеплює молекули целюлози (до чого еукаріотичні організми не здатні). Одним з прикладів мутуалістичних взаємовідносин є запилення квіток рослин комахами (рис. 35). У випадку, коли ті самі рослини можуть запилюватися різними комахами, а комахи живляться пилком і нектаром різних видів рослин і здатні використовувати іншу їжу, говорять про протокооперацію – форму симбіозу, за якої співіснування корисне для обох видів, але не є обов’язковим. У разі взаємовигідних відносин користь, отримувана
вжди є однаковою. Якщо
індиферентними, їх класифікують як вияв коменсалізму –
Рис. 35.
риби-лоцмани (рис. 36).
яких
папоротей, квіткових тропічних рослин (рис. 37). Деревні рослини слугують їм місцем прикріплення, а живляться епіфіти за рахунок відмерлих тканин і виділень господаря та шляхом фотосинтезу. Деякі рослини мають користь від співіснування з тваринами, які вможливлюють розповсюдження плодів і насіння. Із таким співіснуванням пов’язана низка адаптацій. Так, насіння рослин, яке поширюється тваринами, може мати гачечки, щетинки, шипи, клейкі виділення, за допомогою яких кріпиться до шерсті тварин. Плоди рослин, які поширюються тваринами, мають м’ясистий соковитий оплодень як приманку для поїдання (зокрема в калини, горобини, вишні, малини). Організми також вступають в антагоністичні взаємовідносини, до яких відносять хижацтво, паразитизм і конкуренцію. Форму симбіозу видів, за якої організми одного виду (хижаки) живляться організмами іншого виду (жертвою), вступаючи в безпосередній контакт, називають хижацтвом. Найважливішою характеристикою хижаків є те, наскільки вони спеціалізовані на живленні певними видами жертв. Наприклад, звичайна лисиця – еврибіонтний вид, який має широку екологічну нішу за ресурсами живлення. Її жертвами
розміром ссавці, птахи, рептилії, амфібії, найрізноманітніші безхребетні та навіть чимало різних рослин. Прикладом вузької спеціалізації за ресурсами живлення може бути гігантський мурахоїд, який живиться лише мурахами й термітами (рис. 38). З іншими прикладами адаптацій, які формуються в системі «хижак – жертва», ви ознайомитеся в наступному параграфі.
Рис. 36. Риби-лоцмани супроводжують акулу довгокрилу
Рис. 37. Тропічна рослина-епіфіт на дереві Наведіть приклади організмів-коменсалів,
вою його використання). Багато паразитичних організмів
грибів, тварин, трапляються паразитичні рослини, зокрема представники родів повитиця та вовчок (рис. 39). Докладніше про паразитичні організми
дізнаєтеся в § 14. Уже було згадано про конкуренцію
ми екологічними потребами, коли наявність конкурента зменшує можливості користування ресурсами (§ 8). Вимирання певних видів є наслідком їх взаємодії з видами-конкурентами. Наприклад, потрапляння в Австралію здичавілих собак динго призвело до вимирання місцевих хижаків
та сумчастого диявола. Ці хижаки були сильніші від собак, але поступалися собакам у мисливському мистецтві. Ці види збереглися
в Тасманії, куди не дісталися динго. Поміж нейтральних взаємовідносин виділяють аменсалізм – форму взаємозв’язків між організмами різних видів, за якої один вид пригнічує життєдіяльність іншого, але при цьому не зазнає впливу у відповідь. Наприклад, світлолюбні трав’янисті види, що ростуть під деревами, зазнають пригнічення в результаті затінення, натомість для самого дерева сусідство
Дайте означення понять еволюція, природний
адаптація.
Форми взаємодії організмів різних
в екосистемах є виявами міжвидової боротьби за існування.
біологічних систем може виявлятися у взаємному доборі залежних один від одного видів, про що у своїй праці «Походження видів шляхом природного добору…>» говорив
Поняття спряженої
або коеволюції. Подальші дослідження виникнення та становлення взаємозв’язків організмів в угрупованнях привели до виокремлення поняття «коеволюція», яке було застосоване екологами Паулем Ерліхом і Пітером Рейвеном
тку різних видів у складі однієї екосистеми. Як приклад коеволюції наводився опис взаємозв’язку рослини й гусениці. Рослина, захищаючись від поїдання, виробляє отруйні для гусениць речовини. Натомість певні види гусениць, зокрема гусениці метелика монарха, унаслідок еволюції набули нечутливість до рослинних отрут. Більш того, вони накопичують ці отрути у своєму тілі й самі стають неїстівними для птахів.
Рис. 40. Рослина
живляться; види хижих тварин з видами тварин, якими вони живляться; паразитів з їхніми хазяїнами; комах з комахозапильними рослинами тощо. Спряжена еволюція є важливою формою розвитку,
вдосконалення багатьох груп організмів. Результатом коеволюції є взаємні адаптації (коадаптації) двох видів, що забезпечують можливість їхнього спільного існування та підвищення стійкості екосистеми як цілісної
системи. ! Коадаптація – взаємна адаптація різних видів унаслідок спряженої еволюції (коеволюції).
Існування спряженої еволюції
копичення великої кількості наукових фактів.
Явище спряженої еволюції можна проілюструвати прикладами коадаптацій у парі видів хижак – жертва. У хижаків і тварин, якими вони живляться, виробилося захисне забарвлення, що робить їх непомітними на місцевості. У хижаків воно закріпилося завдяки тому, що вони могли непомітно підкрастися до здобичі, а в здобичі – унаслідок того, що жертва залишалася менш помітною для хижаків. Наприклад, комахи, ящірки, жаби, які ховаються між листям рослин, мають зелений
бурий колір, мешканці пустель – пісочний, а мешканці
слугує попередженням хижакам (оси, джмелі, сонечка, колорадські жуки тощо).
У деяких тварин виробилися адаптації, за яких форма тіла та його забарвлення роблять їх схожими на листя, сучки, гілки, кору, колючки рослин і навіть квітки. Часто маскування трапляється в комах, що живуть на рослинах (рис. 42).
Цікавою формою захисних адаптацій у тварин є мімікрія, за якої незахищені види імітують своїм забарвленням і формою тіла захищені види. Наприклад, цикади і цвіркуни нагадують великих мурах, дзюрчалка схожа на отруйну осу, неотруйні змії схожі на отруйних (рис. 43).
Явище спряженої еволюції пояснюють адаптаціями, які виявляються у взаємному впливі рослин і фітофагів. Прикладом може слугувати співжиття мексиканської акації і мурашок, які селяться на її шпичках. Якщо усунути мурашок, то комахи-фітофаги (яких звичайно поїдають мурашки) знищать усе листя акації, без якого дерева гинуть. Важливою адаптацією в таких взаємовідносинах є також утворення рослинами токсинів, що захищають їх від виїдання фітофагами. Між рослинами також відоме явище мімікрії, наприклад, кропива глуха своїми листочками дуже сильно нагадує кропиву дводомну, яка захищена пекучими волосинками від фітофагів.
схожість
слугувати захистом і незахищеному виду. Що давніша система хазяїн – паразит, то меншої шкоди завдає паразит своєму хазяїнові внаслідок коеволюції. Так, в екваторіальній Африці в антилоп
Рис. 42. Маскування тварин: а – листохвостий гекон; б – метелик-листовидка; в –богомол звичайний; г – індійський квітковий богомол
Рис. 43. Мімікрія: а – кораловий аспід (отруйний) і королівська змія (неотруйна); б – двокрила комаха з роду дзюрчалка та оса звичайна




зяїна ми пояснимо в параграфі 14. Незважаючи на уявний антагонізм подібних пар видів, у процесі коеволюції складаються такі взаємовідносини, за яких види-партнери стають певною мірою взаємно необхідними. Наприклад, хижаки, вибраковуючи з-поміж своїх жертв неповноцінних особин, стають важливими регуляторами їхньої чисельності. Природний добір в угрупованнях часто приводить до збереження ознак, сприятливих для популяцій і угруповань загалом, але не вигідних для окремих особин усередині популяцій. Зокрема, концепція коеволюції пояснює факти альтруїзму у тварин: турботу про нащадків, взаємодопомогу, співробітництво тощо (рис. 44). Сучасна наука використовує термін «коеволюція» для позначення механізму взаємозумовлених змін складників цілісної системи, що розвивається. Згідно з принципом коеволюції, людство, для того, щоб забезпечити своє майбутнє, має не лише змінювати
само змінюватися, пристосовуючись до об'єктивних вимог
радикально
засновник кібернетики Норберт
прагнення до діяльності на благо інших. Поняття
альтруїзму ввів французький філософ і засновник соціології Огюст Конт.
Згідно з Контом, принцип альтруїзму звучить: «Живи для інших».
Слони підтримують хворих або поранених особин свого виду, допомагаючи їм дихати та йти. З’ясувалося, що слони здатні виявляти турботу про молодих особин та особин старшого покоління.
11.
Що таке терморегуляція?
Які особливості покриву тіла птахів і ссавців?
Поясніть значення потових залоз у терморегуляції.
Температура є важливим фактором середовища існування, адже вона істотно впливає на перебіг хімічних реакцій у клітинах. Тому організми мають способи адаптуватися до змін цього чинника.
Терморегуляція рослинного організму. Рослини здебільшого ведуть прикріплений спосіб життя, тому вони існують за тих температурних умов, які є в місцях їх зростання. У рослинному організмі утворюється мало метаболічної теплоти, що визначає обмеженість спектру способів терморегуляції. Морфологічна терморегуляція спрямована на запобігання перегріву організму. Прикладами таких адаптацій є густе опушення листя (розсіює частину сонячних променів), глянсувата поверхня (сприяє їх відбиванню). У рослин, які мешкають в умовах жаркого клімату, адаптації спрямовані на зменшення площі листкової пластинки (рис. 45). У холодних умовах засобами запобігання втратам теплоти є особливі життєві форми, наприклад карликові й сланкі, які вможливлюють захист сніговим покривом узимку. Значна частина холодостійких рослин має темне забарвлення, що допомагає краще поглинати теплові промені. До фізичної терморегуляції відносять транспірацію,


ся кристалічного льоду. Це зумовлено накопиченням у клітинах цукрів (до 20–30 %), похідних вуглеводів, деяких амінокислот, гідрофільних білків, які знижують температуру замерзання води, – відбувається адаптація на молекулярному рівні. Терморегуляція тваринного організму. Найважливіша особливість тварин – їхня рухливість, здатність переміщатися в просторі – створює нові адаптивні можливості, у тому числі й у терморегуляції. Тварини можуть активно вибирати місце мешкання зі сприятливішими умовами. Відносно високий ступінь метаболізму й робота
великої кількості енергії, зокрема й теплової.
Етологічні (поведінкові) адаптації є ще одним дієвим способом терморегуляції, адже для багатьох тварин поведінка є єдиним і дуже ефективним засобом підтримання теплового балансу (рис. 46).
Фізична терморегуляція зумовлена особливостями будови організму, які спрямовані на збереження або розсіювання теплоти. Зокрема такими адаптаціями є забарвлення тіла й наявність теплоізолювальних покривів, різна форма частин тіла. Інтенсифікація
ускладненням будови
істотно залежить від температури
середовища (рис. 47). Гомойотермні тварини зберігають постійний тепловий
високу температуру тіла (рис. 48).
Особливості терморегуляції пойкілотермних і гомойотермних тварин. Пойкілотермні тварини вирізняються більш
рівнем обміну речовин порівняно з гомойотермними, навіть за однакової температури тіла. Наприклад, за температури +37 ° C пустельна ігуана споживає
менше, ніж гризуни такого самого розміру. Через знижений рівень обміну в пойкілотермних тварин виробляється мало власної теплоти, тому можливості хімічної терморегуляції в них невеликі. Із пониженням температури середовища всі процеси життєдіяльності дуже вповільнюються, і тварини впадають у заціпеніння. У такому неактивному стані їм властива висока холодостійкість, яка забезпечується біохімічними адаптаціями. Основний спосіб регуляції температури тіла цих тварин – етологічний (активний пошук сприятливих мікрокліматичних умов, зміна місць мешкання тощо). Наприклад, червоноклопи збираються в пошуках тепла на ділянках, добре прогрітих сонцем. У спеку тварини ховаються в тінь або в нори. У пустелях ящірки та змії
ється рядом фізіологічних пристосувань: без’ядерні еритроцити
подвійне дихання в птахів тощо. Одним з важливих чинників, що впливає на терморегуляцію, є розміри тіла. Кількість продукованої теплоти є пропорційною об’єму організму, натомість тепловтрати – площі його поверхні. Свою чергою, об’єм пропорційний лінійним розмірам у третьому степені, а площа – у другому степені (пригадайте з курсу математики формули площі та
). Відтак, менші організми мають більшу питому втрату теплоти, адже в них більше відношення площі до об’єму. Це має наслідком закономірність, установлену німецьким біологом Карлом Бергманом: у гомойотермних тварин одного виду або групи близьких видів розміри тіла більші
холодних частинах ареалу та менші – у теплих (рис. 49). Більша інтенсивність тепловіддачі може досягатися не лише зменшенням загальних розмірів, а й збільшенням відносних розмірів частин тіла, що виступають (лапи, вуха тощо). Тому серед споріднених видів ті, що мешкають у теплому кліматі, будуть мати більші відносні розміри таких частин тіла, порівняно з тими, що мешкають у холодних
Назвіть середовища існування організмів на нашій планеті.
Чим різняться умови існування організмів у цих середовищах?
На нашій планеті мешкають дуже різноманітні організми. Вони населяють усі наявні середовища, які суттєво відрізняються за специфікою умов. Учені вважають, що життя виникло й поширилося спочатку у водному середовищі. Надалі організми опанували наземно-повітряне середовище, а згодом було утворено й заселено ґрунт (рис. 51). Самі організми також стали специфічним середовищем життя для симбіонтів. ! Середовище існування – частина природи, що безпосередньо оточує організми, забезпечує їхні потреби й чинить на них певний вплив. Основними абіотичними чинниками, що впливають на організми в будьякому середовищі, є освітленість, температура, вологість, хімічний склад, тиск, щільність. Найбільший вплив на існування організмів здійснюють лімітувальні чинники – ті,
ганізмів.
Наземно-повітряне середовище. Наземно-повітряне
найрізноманітніше
Рис. 51. Середовища існування організмів на планеті: а – водне; б – наземно-повітряне; в –ґрунтове
вальною паренхімою й велику кількість продихів, сконцентрованих переважно на нижній стороні листка. До цих рослин належать дерева й чагарники (береза, акація, модрина, сосна) трав’янисті рослини степів, рослини напівпустель і пустель, а також водні рослини з розташованими над поверхнею води листками (латаття, лотос). Друга група рослин – тіньовитривалі, пристосована до умов недостатньої освітленості. Поміж тіньовитривалих рослин є деревні форми (наприклад липа, граб, ялина тощо), що мають густу крону, темно-зелене листя. Трапляються й трав’янисті форми, наприклад копитняк, яглиця, підмаренник та інші рослини широколистяних лісів (рис. 53). Тіньолюбні рослини ростуть в умовах тривалого затемнення й не витримують інтенсивного освітлення (рис. 54). Це рослини нижніх ярусів лісу, водних глибин,
листя досить велике, темно-зелене з широкою і тонкою
кою, що сприяє
ґрунтах (конюшина,
росичка, зозулин льон). Посухостійкі рослини ростуть у посушливих місцях, зокрема в пустелях, напівпустелях, степах. Ці рослини мають тонке листя, інколи воно може перетворюватися на колючки (кактуси) або здатне потовщуватись і накопичувати вологу (алое, молодило, очиток). Стебла можуть бути потовщеними, накопичувати вологу й виконувати фотосинтетичну функцію (кактуси). Їхня коренева система добре розвинена. Деякі рослини займають проміжну нішу між вологолюбними та посухостійкими.
За відношенням до вологості повітря тварин поділяють на три групи.
Вологолюбні тварини живуть у сирих вологих місцях – під камінням, біля водойм, на болотах (мокриці, амфібії). Друга група – сухолюбні – живуть у посушливих місцях, пустелях, напівпустелях (пустельні комахи, павукоподібні, рептилії). Покриви тіла таких тварин (рогова луска, кутикула) дозволяють утримувати воду в організмі. Ці тварини активні переважно вночі, коли температура повітря зменшується. До посухостійких відносять переважну більшість тварин (рис. 56).
За відношенням до температури розрізняють холодостійкі та теплолюбні види. Активна життєдіяльність організмів можлива в температурному діапазоні приблизно від 0 °С до + 50 °С. Холодостійкими є види, для існування яких оптимальною є низька температура. До них відносять лишайники, мохи, деякі види бактерій, членистоногих, птахів,
Рис.
Рис. 56. Групи тварин
низький уміст кисню тощо. Мешканців водойм називають гідробіонтами
гічних груп. Планктон утворюють організми, які
протистояти течіям. У них виникла низка адаптацій, що підвищують їхню плавучість і перешкоджають осіданню на дно: загальне збільшення відносної поверхні тіла за рахунок зменшення розмірів, накопичення в тілі жирів, бульбашок газу тощо. Такими організмами є бактерії, водорості, радіолярії, форамініфери, личинки кісткових риб, медузи, дрібні ракоподібні тощо (рис. 57).
Нектон – це організми, які активно рухаються й не залежать від течії. Вони мають обтічну форму тіла, що часто вкрите слизом чи лускою. Ці організми мають розвинену мускулатуру й використовують різні способи руху, у деяких органами руху є плавці або ласти. До нектону відносять більшість видів риб, головоногих молюсків, китоподібних (рис. 58). Перифітон утворюють організми, які оселяються на різних субстратах товщі води й покривають поверхні
кораблів тощо. До
Мешканці
(рис. 60).
водорості, губки, кільчасті черви, двостулкові молюски, ракоподібні (рис. 61).
Уміст кисню у воді менший, ніж в атмосфері. Концентрація кисню залежить від глибини водойми – що глибше, то вона нижча, та від температури й солоності води – із їх підвищенням концентрація кисню зменшується. Температурний режим водойм досить сталий. Це пов’язано з фізичними властивостями води (висока питома теплоємність). Найбільші коливання температури спостерігаються у поверхневих шарах. Світла у воді значно менше, ніж у повітрі. Освітленість зменшується в напрямку збільшення глибини, що істотно впливає на інтенсивність фотосинтезу рослин. Так, водорості мешкають не глибше за 250 метрів. Адаптацією до зростання на глибині є різне забарвлення талому, зумовлене складом хлорофілів та інших фотосинтетичних пігментів. Червоні водорості містять фікобіліни, які поглинають сині та фіолетові промені (пригадайте, яка особливість поширення червоних водоростей із цим пов’язана), а бурі водорості – ксантофіли (рис. 62). На глибину 1500 метрів світло взагалі не проникає. Такі умови освітленості значно обмежують можливості
гідробіонтів. Глибоководні
життєдіяльності.
му рослин, підземні частини яких поглинають необхідні сполуки і
функцію закріплення. Кореневі системи рослин симбіотично взаємодіють із грибами, формуючи мікоризу. На поверхні ґрунту живуть водорості, гриби, лишайники, ціанобактерії, одноклітинні організми. У товщі ґрунту живуть як хемосинтезувальні бактерії, так і гетеротрофи. Поміж тварин у ґрунті мешкають види різних груп, зокрема деякі комахи, круглі черви, кільчасті черви, членистоногі, хребетні. Деякі організми проводять у ґрунті лише частину життєвого циклу (наприклад личинки певних комах). У зв’язку з великою щільністю середовища в багатьох тварин розвинулися певні адаптації
сування в ґрунті, зокрема риючі кінцівки, червоподібний рух, укрита слизом шкіра (рис. 63). У цьому параграфі
розвиваються численні адаптації до впливів одне на одного, що є
із
можуть бути як поверхні тіла організмів, так і їх внутрішні порожнини. У якості квартирантів можуть виступати прокаріоти, одноклітинні еукаріоти або ж багатоклітинні організми різних груп. Симбіонти можуть траплятися навіть в одноклітинних організмів. Такі взаємодії
розглянутих раніше (§ 9) типів, але зважаючи
ганізмами, частіше трапляються
та паразитизму (§ 14). Взаємовигідні взаємодії
із прикладів мутуалізму
водоростей у тканинах тридакни. Таке явище
тварин, що мають у своїх
зу, але зелений відтінок забарвлення допомагає їхньому маскуванню. Частіше за водоростей у якості симбіонтів виступають бактерії. Раніше ми пригадували бульбочкові бактерії в рослин. Нормальна мікрофлора має важливе значення для функціонування організму хазяїна (рис. 66). Заселяючи доступні ділянки, вона запобігає розвитку патогенних. Бактерії можуть синтезувати корисні для хазяїна сполуки. Кишкова паличка в людини утворює вітамін K. Іншим відомим прикладом є бактеріальні симбіонти джгутикових одноклітинних, що мешкають у травному тракті рослиноїдних тварин, уможливлюючи перетравлення ними целюлози (терміти, жуйні ссавці). Дисбаланс видового складу кишкової мікрофлори може супроводжуватися порушенням здоров’я та розвитком хвороб. Дослідження взаємодії мікробіому та функціонування організму хазяїна є актуальним напрямом сучасних
Ендосимбіоз.
Рис. 65. Лінивець Рис. 66. Мікробні
Що таке паразитичні організми?
параграфі ми
приклади переважно взаємовигідних взаємодій організму хазяїна та симбіонта. Поняття паразитизму. Проте часто буває і протилежне
співмешканець використовує хазяїна в якості джерела поживних речовин. Такі організми називаються паразитами. ! Паразитизм – форма симбіозу організмів різних видів, з яких один (паразит) використовує іншого (хазяїна) як середовище мешкання та джерело живлення, покладаючи на нього (частково або повністю) регуляцію відносин з навколишнім середовищем. Паразитичний спосіб існування можуть вести організми всіх груп – прокаріоти, одноклітинні еукаріоти, рослини, тварини, гриби. Залежно від локалізації виділяють екто- та ендопаразитів. Ектопаразити – паразити, що живуть на поверхні тіла хазяїна (рис. 67). Паразитичні організми, що живуть усередині тіла хазяїна, називають ендопаразитами (рис. 68). Відоме також явище суперпаразитизму, за якого хазяїн певного паразита є, у свою чергу, паразитом іншого хазяїна. Залежно від часу паразитування паразитів поділяють на тимчасових та стаціонарних. Тимчасові – це
лишньому середовищі,
Рис. 67. Ектопаразити
Рис. 68. Ендопаразити.
чачий ціп’яки).
також паразитів облігатних і факультативних. Облігатні паразити не здатні жити й розмножуватися без живлення поза організмом хазяїна (наприклад аскариди, гострики, солітери). Факультативні паразити здатні самостійно жити й розмножуватися без живлення тканинами та соками хазяїна (наприклад амеба дизентерійна).
Поширення паразитизму поміж різних груп організмів. Паразитизм поширений у всіх групах організмів – бактеріях, рослинах, грибах і тваринах. Можна помітити пряму залежність кількості видів-паразитів у
груп організмів
перебуває. Поміж рослин можна виділити напівпаразитичні організми, які
хлорофіл і здатні синтезувати органічні речовини за рахунок світлової енергії, зокрема омела. Інші рослини-паразити не містять хлорофілу, тому живляться лише за рахунок рослини-хазяїна, зокрема повитиця (рис. 69).
Багато паразитичних форм є поміж грибів. Це різні види сажкових, іржастих, борошнисторосяних грибів, які викликають захворювання (рис. 70). Поміж шапинкових грибів усім відомий трутовик, що паразитує на стовбурах дерев. Захворювання людини, спричинені
зивають
льоз, дифтерія, черевний тиф,
ботулізм тощо.
Багато паразитичних видів тварин є поміж плоских, круглих і кільчастих червів, молюсків, членистоногих (пригадайте види,
якими
ознайомилися під час вивчення тварин).
Адаптації паразитів до мешкання в організмі хазяїна. Існування паразитів у специфічному середовищі зумовлює деякі особливості їхньої будови, фізіології та розмноження. У червів, що перейшли до паразитичного способу життя, відбулося збільшення розмірів тіла порівняно з вільноживучими видами (наприклад бичачий ціп’як, стьожак широкий, нематоди тощо). До адаптацій можна віднести розвиток органів прикріплення – присосок, гачків, шипів (рис. 71). Ускладнюються та спеціалізуються ротові апарати в кровосисних комах (рис. 72). У рослин-паразитів виникли гаусторії – видозміна коренів, які забезпечують живлення та прикріплення до субстрату. Через те, що чинники зовнішнього середовища впливають на паразитів переважно через організм хазяїна, розвиваються регресивні адаптації. До них можна зарахувати спрощення або повну втрату
чи
систем (травної, кровоносної, нервової, органів чуття). Паразитичні організми мають
плодючість:
яєць, цист і спор. Поміж них поширений
та
його знищення. Виділяють клітинну реакцію як адаптаційний механізм
нізму хазяїна, що виявляється в збільшенні розмірів клітин, які містять паразитів. Створення навколо паразита сполучнотканинної капсули, що ізолює його, називають тканинною реакцією. Імунологічна реакція полягає у створенні в організмі хазяїна антитіл у відповідь
що їх виробляє
Існують чинники, що зумовлюють різні ступені адаптації організму хазяїна до паразита. Поміж них варто зазначити негативні, як-от: вік, характер харчування, порушення ендокринної регуляції, хронічні захворювання тощо. Деякі чинники є спадковими. Наприклад, люди із генетичним захворюванням серповидно-клітинною анемією мають підвищену стійкість до малярії. Річ у тім, що еритроцити патологічної форми, заражені плазмодієм, активніше знищуються клітинами імунної системи. Через це
переривається. Захворювання є аутосомно-рецесивним (рис. 74). Що більше у крові видозмінених еритроцитів, тим більшою є стійкість до малярії.
поширення серповидно-клітинної
де малярія є ендемічним захворюванням, що можна розглядати
систем
Назвіть рівні організації живого. Наведіть приклади періодичних змін екологічних чинників, які впливають на біологічну систему.
Екологічні чинники часто впливають на біологічні системи ритмічно. Це спричинює формування
логічних ритмів. ! Біологічні ритми – циклічні
цесів життєдіяльності, в основі яких лежать кількісні та якісні зміни метаболізму біологічних систем.
Типи адаптивних біологічних ритмів. За чинниками біологічні ритми поділяють на зовнішні та внутрішні. Зовнішні біологічні ритми пов’язані з циклічними змінами в навколишньому середовищі. До них належать добові, припливно-відпливні, сезонні, річні та багаторічні ритми.
Добові ритми зумовлені обертанням Землі навколо своєї осі. Двічі на добу змінюється освітленість, що зумовлює коливання абіотичних чинників (температури, вологості тощо), які впливають на активність організмів. У рослин зміни освітленості викликають періодичність процесів фотосинтезу, транспірації, закриття та відкриття квіток тощо (рис. 75). Зміна дня і ночі впливає на різні функції організмів тварин: рухову активність, інтенсивність процесів обміну речовин тощо (рис. 76). У
Рис. 75. Приклади добових ритмів у рослин Рис. 76. Приклади тварин із різними добовими ритмами
в схованках) (рис. 77).
Сезонні ритми зумовлені обертанням Землі навколо Сонця. Відтак виникають сезонні явища. Зі зміною сезонів пов’язані важливі життєві функції організмів: анабіоз, линяння, міграції, розмноження, розвиток, листопад тощо (рис. 78). Можливі впливи сезонних ритмів навіть на будову організмів (у попелиць, дафній – розміри тіла, будова окремих частин).
Річні та багаторічні ритми пов’язані з змінами сонячної активності та інших чинників протягом кількох років. Ці ритми виражені не так чітко, як сезонні. Прикладом багаторічних циклів є масові розмноження перелітної сарани й деяких інших тварин (рис. 79).
Внутрішні біологічні ритми зумовлені життєдіяльністю організмів (ритм дихання, серцевий цикл, травлення, виділення). Існування періодичних змін довкілля зумовлює виникнення адаптивних біологічних ритмів у живих істот. З ними пов’язане явище «біологічного годинника» – здатності організмів реагувати на плин часу. Воно дає змогу узгоджувати фізіологічні ритми організмів зі змінами навколишнього середовища.
температури,
впливають на біологічні ритми, є фотоперіод
Рис. 77. Приклад припливновідпливних ритмів Рис. 79. Приклад



речовини (фітогормони), які впливають на різноманітні процеси життєдіяльності (цвітіння, листопад, проростання насіння, бульб, цибулин тощо). Залежно від реакції на довжину світлого періоду доби розрізняють рослини довгого (рис. 80) та короткого дня (рис. 81). Рослини короткого дня здебільшого зростають у приекваторіальних областях, довгого – у помірних широтах і полярних областях. Фотоперіодизм чіткіше виражений у рослин короткого дня. Він відіграє роль у географічному поширенні рослин і в регуляції їхнього сезонного ритму. У тварин фотоперіодизм контролює настання й припинення парувального періоду, плодючість, линяння, міграції, перехід до зимівлі тощо. А фотоперіодичні реакції регулюються нервовою й ендокринною системами. За відношенням до світла тварин поділяють на групи залежно від їхнього способу життя: денні та нічні. У людини фотоперіодизм виражається переважно в коливаннях інтенсивності обміну речовин і енергії. Шляхи пристосування організмів до періодичних змін умов середовища мешкання. Різні організми пристосовуються до однакових умов мешкання по-різному. Розрізняють активні, пасивні пристосування й уникання несприятливих умов. Під час
власні
цесів обміну речовин, вони впадають у стан заціпеніння. Деякі
тварини (їжаки, бурі ведмеді) впадають у
сплячку (рис. 82). Листопадні рослини взимку припиняють фотосинтез, ріст і розвиток. Щоб уникнути несприятливих умов, тварини переміщуються в інші місця (міграції та кочівлі деяких комах, риб, птахів, ссавців тощо) або найвразливіші фази розвитку завершують у найсприятливіші періоди, а на несприятливі періоди припадають фази спокою (наприклад фази яйця або лялечки в комах). Внутрішній механізм формування добової ритміки.
циркадні ритми впливають не лише зовнішні чинники (світло), а й перебіг внутрішніх процесів, зокрема зміна активності певних генів. Ключова роль у цьому належить гену per (period), продукт якого – білок PER
діє як транскрипційний фактор, гальмуючи власну активність. Синтезований білок за деякий час піддається руйнуванню, унаслідок чого гальмування зменшується, а синтез відновлюється. У такий спосіб у клітині формується циклічне коливання PER. У людини ген per найбільш активний у клітинах гіпоталамуса, які регулюють утворення гормону мелатоніну, який своєю чергою впливає
ня, так відбувається
доби. Проте описана ритмічність встановлюється і
ших зовнішніх чинників. Відтак добова ритміка впливає на перебіг фізіологічних функцій, працездатність і самопочуття (рис. 83).
Рис. 82. Тварини, які впадають у зимову сплячку
1.
2. Перелічіть типи адаптивних
3.
4.
5.
6.
Рис. 83. Ритмічні зміни деяких фізіологічних параметрів протягом доби в людини
1.
2.
3.
Індивідуальне
Дослідження Гаузе
Paramecium у пробірках, куди він добавляв вівсяне борошно. На ньому розвивалися дріжджі й бактерії, якими харчувалися інфузорії. У таких умовах, окремо один від одного, усі три види роду Paramecium успішно розвивалися (див. графіки А, Б, В). За сумісного існування двох різних видів результати дослі-
дження виявилися іншими (див. графіки Г, Д). Науковець також
встановив, що види P. сaudatum й P. вursaria
відрізнялися за своїм способом живлення:
перший вид живився бактеріями в товщі
рідини, другий – дріжджовими клітинами при дні».
Завдання 1. Який метод
А порівняльно-описовий
Б експериментальний
В моделювання
Г моніторингу
Індивідуальне
Кораблі пустелі
Двогорбих верблюдів – бактріанів – називають «кораблями пустелі». До існування за високих температур і нестачі води ця тварина має низку адаптацій. Щільна шерсть не пропускає гаряче повітря до шкіри. Жировий горб також відіграє захисну роль, бо, як відомо, жир – поганий провідник тепла. Крім того, жирова тканина горба є джерелом метаболічної води. Ніздрі зі щільними клапанами відкриваються строго на час вдиху і видиху, щоб не випаровувати зайвого.
Послід верблюда гранично сухий, а сеча надзвичайно концентрована – нирки залишають у ній мінімум води.
Верблюди виділяють з організму набагато менше води, ніж
людина за тих самих умов. Пояснюється це тим, що у верблюдів у літню спеку значно коливається температура тіла: вночі падає до 34 ° С, а вдень доходить до 40 ° С. Ці тварини виділяють піт лише після того, як температура їхнього тіла, повільно підвищуючись, досягне 40 ° С, а в людини потовиділення починається відразу, коли температура навколишнього повітря стає вища за температуру тіла В екстремальних ситуаціях верблюду вдається вижити, навіть втративши до 40 % маси тіла, натомість більшість ссавців
організму. У верблюда ж навіть під час значних втрат
віддають інші тканини. Крім того, поміж усіх ссавців
ні еритроцити, які добре рухаються навіть
зневодненні. Завдання 1. Яке з пропонованих тверджень можна сформулювати на
аналізу наведеної інформації?
А унаслідок розщеплення жиру вода не утворюється Б адаптації у верблюда пов’язані лише
Індивідуальне завдання
Мурахи й комахоїдна рослина
Ознайомтеся з інформацією:
«Біологи описали цікавий приклад симбіотичних відносин між мурахами Camponotus schmitzi, що мешкають на Калімантані, і комахоїдними рослинами непентесами (Nepenthes bicalcarata).
Непентес мешкає на бідних поживними речовинами торф'яних болотах і змушений отримувати Нітроген та інші елементи від комах, що падають у своєрідний
глечик (ловчий апарат) із травними ферментами. Виявляється, що в цьому рослині допомагають інші комахи – мурахи. Учені порівняли непентеси, заселені й не заселені мурашиними колоніями. З’ясувалося, що в тих рослинах, які позбавлені сусідів-мурашок, уміст
но, рослини, позбавлені
порушення синтезу А білків
Б ліпідів
В моносахаридів
Г полісахаридів
Завдання 2. Як непентес додатково отримує Нітроген?
А перетравлюючи мурашок, які потрапляють у ловчий апарат рослини
Б унаслідок симбіотичних відносин з нітрифікувальними бактеріями В з ґрунту торф’яних боліт, багатих поживними речовинами
1.
Тестові
3. Випадкову зміну частоти
А міграцією Б ізоляцією В дрейфом генів Г популяційними хвилями
4. Яка видозміна листків є пристосуванням рослини
умовах?
А вуса полуниці
Б вусики гороху
В колючки кактуса
Г ловчі листки росички
5. На рисунку наведено приклад взаємозв’язків
між різними видами. Укажіть його.
А хижацтво
Б мутуалізм
В паразитизм
Г коменсалізм
6. Укажіть організми різних видів, один з яких певний час використовує
джерело живлення та середовище мешкання.
А ціп’як бичачий і корова
Б ховрах степовий і миша польова
В підберезник твердуватий і береза
Г павук-хрестовик і бджола медоносна
Тестове завдання з коротким описом
А 1, 2
Б 2, 4
В 3, 5
Г 4, 6
8. Прочитайте речення: «Крило кажана та
ний варіант.
А 1 – гомологічними
Б 1 – аналогічними
В 1 – рудиментарними
Г 1 – гомологічними
9. Прочитайте твердження щодо
змін зображених тварин.
І. Обидві тварини пристосовані до
ІІ. Можливий шлях виникнення обох видів –
адаптивна радіація.
Чи є поміж них правильні?
А правильне лише І
Б правильне лише ІІ
В обидва правильні
Г немає правильних
Тестове завдання з
сандрійським лікарям Герофілу
трупів і досліди на тваринах. Великий вплив на розвиток
(1628 р.), заклавши
розвитку сучасної фізіології.
філактична.
(1796 р.). Роботи Луї Пастера (1822–1895), який установив
отримав Нобелівську премію з
сучасними
і надзвичайно хворим станами. Всесвітня організація охорони здоров’я (ВООЗ) визначає це поняття так: ! Здоров’я – це стан повного фізіологічного, розумового та соціального благополуччя, не лише відсутність захворювань та ушкоджень організму. Складники здоров’я. Відповідно до цього означення можна виокремити складники здоров’я. Фізичне здоров’я передбачає цілісність і нормальність будови тіла, нормальне перетікання біохімічних і фізіологічних процесів за різних (не екстремальних) умов. Психічне здоров’я – це нормальний перебіг процесів мислення, пам’яті, уваги, емоцій, почуттів тощо. Соціальне здоров’я характеризує нормальність взаємодії конкретної людини із іншими членами соціуму, формування соціальних зв’язків, організації роботи, відпочинку, побуту тощо. Cкладники здоров’я є взаємопов’язаними (рис. 84). Здоров’я може порушуватися, а ступінь такого порушення бути різним. Люди можуть мати незначні вади, які не заважають життєдіяльності (шрами, зубні пломби). Нормальний стан також може включати
помірний рівень стресу тощо. Істотне порушення життєдіяльності ми розглядаємо як хворобу.
Рис. 84. Структура здоров’я
Проаналізуйте схему. Поміркуйте, у який її сектор можна помістити:
• відносини з родиною та друзями;
• самооцінку та емоційний стан;
• темперамент та інтелект;
• негативний вплив наркотичних речовин;
• генетичні хвороби;
• набуті фізичні травми;
• будову та функціонування тіла;
• доброзичливе спілкування;
• уміння приймати зважені рішення.
що не можливе, сучасна
симптомів. Тому потрібно якомога раніше діагностувати патологію й починати профілактичні та корегувальні заходи. Одним зі шляхів профілактики розвитку спадкових хвороб є медико-генетичне консультування. Успіхи сучасної науки дають надію на розроблення в майбутньому ефективних методів лікування генетичних хвороб (§ 47). Спадкові чинники здоров’я
розвиток не лише генетичних хвороб. Деякі розлади визначаються не
спадковою інформацією, а й чинниками середовища – у такому випадку ми говоримо про успадкування схильності до виникнення хвороби. У
випадках певні алельні версії генів можуть зумовлювати меншу
негативних чинників середовища існування (стресорів, інфекційних
тощо). Вплив деяких чинників середовища на здоров’я може мати епігенетичне підґрунтя (пригадайте регуляцію активності генів).
За даними ВООЗ, щороку понад 12 млн людей помирають унаслідок проживання або роботи в шкідливому середовищі (рис. 85). Чинниками ризику може бути забруднення повітря, води, ґрунтів, дія неприродних хімікатів, зміни клімату, надмірне ультрафіолетове опромінювання. Забруднена
може бути джерелом кишкових інфекцій
рії) та паразити. Завдяки покращенню
женню рівня забруднення довкілля, профілактичному щепленню та боротьбі з природними переносниками збудників, смертність від інфекцій в останнє десятиліття істотно зменшилася. Спосіб життя людини є також важливим чинником, який впливає на здоров’я людини. Вивчення особливостей функціонування організму людини, впливу різноманітних чинників на нього вможливлює формулювання принципів здорового способу життя, зокрема раціональне харчування, забезпечення певного рівня фізичної активності, уникнення шкідливих звичок тощо (більш детально ми розглянемо це в § 23). Протягом історії людства значущість різних чинників здоров’я зазнавала істотних змін (рис. 86). Науки, що вивчають здоров’я людини. Оскільки здоров’я є комплексним поняттям, його досліджують різні галузі науки. Базові особливості будови та механізми функціонування організму людини є об’єктами вивчення біологічних наук, зокрема анатомії, фізіології, цитології,
лярної біології. Загальні закономірності успадкування ознак вивчає генетика. Розуміння взаємозв’язків людини
вивченні екологічних
формування патологій, пов’язаних з порушеннями генетичного матеріалу, розроблення та впровадження методів діагностики генетичних хвороб, їх профілактика й лікування.
ни пов’язана також з еволюційною
оскільки досліджує конкретні механізми еволюції. Предметом вивчення
є
впливу на організм та суспільне здоров’я комплексу чинників навколишнього середовища. Своєю чергою ці закономірності є підґрунтям розроблення гігієнічних норм, санітарних правил, запобіжних і
заходів (рис. 87). Підтримка ментальної та соціальної норми є об’єктами вивчення психології та соціології. Психологія вивчає механізми й закономірності формування психічних явищ. Соціологія – наука, що вивчає людське суспільство. Разом вони досліджують чинники, які формують переважно психічну складову здоров’я (рис. 87). Важливе значення для збереження
і практичні дисципліни, як-от інженерна психологія та ергономіка, що
вості взаємодії
в ті
часи слугують, наприклад, результати розкопок поселень і поховань первісної людини. ! Хвороба – істотне порушення здоров’я, яке супроводжується зниженням якості життя та порушенням будови й життєдіяльності організму. Перелік відомих хвороб та їх класифікація затверджені Міжнародним класифікатором хвороб, що розроблений Всесвітньою організацією охорони здоров’я (рис. 88). Універсальна система класифікації хвороб є важливою для взаємодії систем охорони здоров’я різних країн, обміну досвідом і впровадження передових методик діагностування та лікування. Хвороби можна об’єднувати в групи за різними ознаками: внутрішні, хірургічні, спадкові, онкологічні, інфекційні, такі, що передаються статевим шляхом тощо. Причини хвороб. Причини хвороб можуть бути найрізноманітніші: зовнішні стосовно організму чинники (механічні, фізичні, хімічні, біологічні), вроджені (генетичні), психогенні та соціальні чинники тощо. Незадовільний стан довкілля, нездоровий спосіб
сприяти
здоров’я. За особливостями поширення в людських
паразитарні хвороби,
ми твариноподібними
установа
Об'єднаних Націй, яка опікується проблемами охорони здоров’я у світовому масштабі. Штаб-квартира ВООЗ розташована в Женеві. До складу входять 193 країни, у тому числі й Україна. Особливу увагу ВООЗ приділяє семи дням і одному тижню, які, на вимогу держав-членів ВООЗ, визнані офіційними глобальними кампаніями охорони здоров’я: Всесвітній день здоров’я (7 квітня), боротьби з туберкульозом, з малярією, зі СНІДом, з гепатитом, день без тютюну, день донора крові, тиждень імунізації.
цгеймера, Паркінсона тощо. Шляхи зараження інфекційними агентами. Знаючи шляхи
ня інфекційними агентами (рис. 89), можна
них заходів, що особливо важливо
масових спалахів захворювань. Хвороби дихальної системи часто поширюються повітряно-крапельним шляхом. Людина, яка хворіє, може чхати, кашляти, унаслідок чого поширює навколо себе мікрокраплини слизу, що містять інфекційний агент. Люди, які не хворіють і перебувають поруч, можуть вдихнути їх та заразитися. Описані реакції є результатом впливу на організм людини збудника хвороби, що є його адаптацією до поширення. Типовим способом поширення кишкових інфекцій та інвазій є фекально-оральний (див. рис. 89). Збудник виходить з організму в складі калових мас, після чого в разі недотримання особистої гігієни з водою або їжею потрапляє до організму. Організм людини може бути середовищем існування багатьох кишкових паразитів (дизентерійна амеба, людська аскарида, сисуни, стьожкові черви тощо), а їхні життєві цикли можуть включати стадії розвитку в інших організмах. У такому випадку людина може заразитися, споживаючи неякісні м’ясо, рибу, воду, контактуючи зі свійськими тваринами тощо. Трансмісивні хвороби поширюються за допомогою тваринпереносників. Це можуть бути комарі (малярія, див. рис. 90), мухи (сонна хвороба), кліщі (кліщовий енцефаліт, хвороба Лайма), блохи (чума), воші (тиф) та інші організми. Часто збудник хвороб людини може мешкати в популяціях диких тварин, які є природним резервуаром. Для профілактики таких хвороб необхідно контролювати






лику групу становлять захворювання, що передаються статевим шляхом (ЗПСШ). Їх збудниками
бути
(ВІЛ-інфекція, герпес, гепатит В, папілома), бактерії (гонорея, сифіліс, хламідіоз), гриби (кандидоз) і найпростіші (трихомоніаз). Наслідками цих хвороб можуть бути втрата сексуальної функції (імпотенція), безпліддя та системні захворювання, що можуть призвести до смерті. За даними ВООЗ, щодня близько 1 млн людей інфікуються ЗПСШ. Для профілактики потрібно пильнувати своє сексуальне життя: уникати випадкових статевих контактів, завжди користуватися презервативом, який, обмежуючи контакт слизових оболонок статевих органів партнерів, істотно зменшує ризик передачі збудника. Варто зауважити, що багато ЗПСШ мають тривалі приховані періоди, під час яких видимих симптомів ще немає, але ймовірність передання збудника (зараження) є високою. Тому використання презерватива має бути обов’язковим елементом статевого життя. Окрім профілактики хвороб, презерватив забезпечує контрацепцію – запобігання небажаній вагітності. Рання діагностика небезпечних хвороб є запорукою ефективного лікування або зменшення негативних наслідків – у більшості регіонів існує можливість пройти анонімне лабораторне обстеження (рис. 91).
Динаміка розвитку хвороб. У динаміці розвитку хвороб виділяють періоди: прихований (латентний, для інфекційних хвороб – інкубаційний), коли хвороботворний агент уже потрапив до організму, але симптоми ще не виявляються; продромальний
не достатньо
91. Данило Заболотний (1866–1929)
дозволяють оцінити втрачені
здоров’я. Світова першість за цим показником належить інфекційним хворобам, насамперед за рахунок країн з низькими рівнями економічного розвитку та доступу до медицини (рис. 92). У країнах з розвинутою економікою на перших позиціях серцево-судинні (переважно інфаркт та інсульт) та онкологічні хвороби, а також травмування (зокрема внаслідок ДТП). Найбільш небезпечні хвороби. Багато хвороб є безпосередніми причинами смертей. Багато життів забирають інфекційні хвороби: інфекції дихальних шляхів, кишкові інфекції, туберкульоз. ВІЛ-інфекція раніше
10 головних причин смертності, проте за сучасними даними смертність від ВІЛ знизилася, і ця хвороба
провідними причинами смертності є
(розумова слабкість, наприклад хвороба Альцгеймера), онкологічні захворювання дихальних шляхів, цукровий діабет і травми внаслідок дорожньо-транспортних пригод. Розуміння біологічних основ поширення
Сучасний прогрес
Пригадайте, які біологічні відкриття зумовили розвиток медицини.
Хвороби забирають час і якість повноцінного життя, тому їх подолання є однією з найбільш актуальних завдань, що стоять перед людством. Успіхи медицини. Медицина має кількатисячолітню історію, протягом якої накопичено численні відомості стосовно способів лікування різних хвороб. Кілька років тому редакція одного з найстаріших і найвпливовіших медичних журналів «British Medical Journal» назвала ключові віхи в розвитку медицини. До них віднесли розуміння
хвороб і відкриття антибіотиків, що спричинили революцію в подоланні інфекцій. Винайдення вакцинації та її масове впровадження вможливили профілактику
них хвороб, що істотно зменшило зумовлену ними смертність (рис. 93). Винайдення анестезії (наркозу) викликало революцію в хірургії, зменшивши біль і страждання пацієнтів. Запровадженням цієї практики у вітчизняну хірургію завдячуємо видатному лікарю Миколі Пирогову. Істотне покращення діагностики хвороб
редколегії «British Medical Journal» були
інші
та
інновації, проте найбільше голосів отримала так звана «санітарна революція» у Великій Британії. Індустріалізацію країн Європи XIX століття супроводжувало стрімке зростання щільності міського населення, через що нерідкими були епідемії інфекційних хвороб, у тому числі кишкових, через забруднені воду та їжу (рис. 95). Для їх подолання було розроблено подібну до сучасної систему водопостачання будинків і відведення стічних вод. Цей крок істотно покращив епідеміологічну ситуацію та стан здоров’я населення. Наведений приклад ілюструє необхідність не лише власне лікування, а й запобіжних заходів – профілактики. За сучасними оцінками, здоров’я та довголіття залежить від активних медичних дій лише на 10 %. Більш істотними є чинники, які піддаються контролю та змінам (рис. 96). Вчасна вакцинація шляхом щеплення захищає від ризику захворіти на найбільш небезпечні хвороби: гепатит В, туберкульоз, дифтерію, правець, коклюш, поліомієліт, кір. Важливою передумовою збереження здоров’я та профілактики хвороб є створення здорового середовища існування, найважливіше значення в якому мають якість повітря та води. І нарешті, істотним чинником є
людини. У наступних
до Лондона проблеми мав і тогочасний Київ. Побудована в ньому наприкінці
Імунітет і його типи
Що таке регуляторні системи організму людини? Як синтезуються білки? § 19.
Середовище, у якому ми мешкаємо, не є ідеальним: щодня нас атакують численні інфекційні агенти. Більшість таких атак ми не помічаємо, оскільки наш організм успішно їх відбиває за допомогою імунної системи (рис. 97). ! Сукупність реакцій, скерованих на підтримку генетичної сталості організму й боротьбу зі збудниками захворювань, називають імунітетом. Класифікація типів імунітету. За механізмом реалізації розрізняють клітинний і гуморальний імунітет. Перший здійснюється спеціалізованими імунними клітинами (лімфоцитами крові), другий – за допомогою різних хімічних речовин. За особливостями розвитку в часі розрізняють уроджений (спадковий) і набутий імунітет. Набуті форми
тягом життя людини і не передаються
імунітет. Обидва типи можуть
моральних
Неспецифічний гуморальний імунітет. Цей тип забезпечується хімічними речовинами, яким притаманна протимікробна та противірусна дія широкого спектру. Лізоцим – фермент, який міститься в різних слизових оболонках організму людини, а також у слині. Він руйнує компоненти клітинних стінок грам-позитивних бактерій. Хлоридна кислота
убиватися чужорідні клітини та клітини власного організму, інфіковані вірусами або ж генетично змінені. Цей тип імунітету забезпечується переважно окремим типом лейкоцитів крові –NK-клітинами (NK – від англ. natural killers, «природні вбивці»). Знищення чужорідних агентів також може здійснюватися макрофагами – клітинами тканин, здатними до фагоцитозу. Специфічний гуморальний імунітет. Цей тип імунітету пов’язаний з виділенням спеціалізованих захисних білків – антитіл або імуноглобулінів. Вони продукуються одним з типів клітин крові – B-лімфоцитами. Антитіла здатні високоспецифічно зв’язуватися з антигенами
чужорідними білками або глікопротеїнами, які виробляються інфекційними агентами. Висока специфічність означає, що антитіло ефективно зв’язується лише з певним, «своїм» антигеном (рис. 98). Таке зв’язування приводить до його знешкодження. Це може відбуватися в різний спосіб: шляхом своєрідного «склеювання» мікроорганізмів, руйнування їхніх клітин, хімічного зв’язування білкових токсинів. Кожний B-лімфоцит
конкретного антигену. Цікаво, що ці клітини не мають
конкретних антитіл.
Специфічний клітинний
за
розпізнавати чужорідні
поверхні інших клітин. Контакт з антигеном ініціює початок інтенсивного поділу лімфоцита. Більша їх частина стає Т-кілерами, які здатні вбивати специфічний тип чужорідних клітин. Інший тип Т-клітин – Т-хелпери – необхідний для забезпечення взаємодії між Т- і В-лімфоцитами для запуску розмноження останніх. Саме Т-хелпери уражаються вірусом імунодефіциту людини, що призводить до розладів імунної функції організму. Третій тип – Т-супресори, пригнічує розвиток імунної реакції, що є необхідним на завершальних стадіях хвороби. Цікавим питанням є те, чому імунна система не формує клітини, специфічно чутливі до власних антигенів. Науковці вважають, що такі клітини утворюються, проте на етапі дозрівання знищуються. Для ефективного захисту
всіх описаних ланок імунної системи. Відповідно
проти певного збудника – імунної сироватки. Вона використовується, якщо
швидко побороти наявний у крові
Імунний захист при цьому триває недовго. Поняття алергії. Особливою формою імунної відповіді є алергія. Вона виявляється як підвищена реактивність на певні антигени, на які за нормальних умов імунна реакція не розвивається (пилок квітів, шерсть тварин, тощо) – алергенів (рис. 101). Зовнішніми виявами алергії є набряки слизових оболонок, розвиток запальних процесів (збільшення кровообігу в локальній ділянці шкіри, набряк, почервоніння, свербіння), підвищена чутливість верхніх дихальних шляхів (кашель, чхання, нежить). Більшість цих симптомів викликана виділенням у тканинах речовини гістаміну. Таким чином, алергія – це реакція гіперчутливості імунної системи,
1.
2.
4.
5.
6.
Як працює імунна система?
Природний активний імунітет – головний шлях боротьби з інфекційними захворюваннями, що сформувався
Поняття імунотерапії. Для ефективної боротьби з небезпечними хворобами імунітетові інколи потрібна «допомога». ! Імунотерапія – це спосіб лікування захворювань шляхом активації або пригнічення функціонування імунних механізмів організму людини. До них належить розглянуте раніше використання імунних сироваток. Сироватки виготовляють із крові імунізованих до певного збудника людей або тварин, переважно коней. Широко застосовують сироватки проти токсинів небезпечних інфекційних збудників (дифтерії, правця, ботулізму), отрути змій, збудників хвороб (грипу, сибірки, кліщового енцефаліту, лептоспірозу та інших). Метод лікування імунними сироватками отримав назву серотерапія. Досягнення в цій галузі були високо оцінені науковцями (рис. 102) Важливим методом імунотерапії є вакцинація. Вакцина – це вбитий або ослаблений збудник хвороби, який зберігає здатність активувати
і В-лімфоцити для формування імунної
разі контакту зі справжнім збудником імунна система реагує швидко й ефективно, забезпечуючи несприйнятливість організму до інфекції. Вакцинація дозволила людству повністю здолати натуральну віспу, а також істотно покращила ситуацію з іншими небезпечними інфекціями: гепатитом В, туберкульозом, дифтерією, правцем, коклюшем, поліомієлітом, коровою інфекцією тощо. До винайдення
Рис. 102. Еміль Адольф фон Берінг (1854–1917)

дорослим людям не можна робити щеплення за медичними протипоказаннями, деякі види щеплень мають вікові обмеження та й ефективність вакцинації не є стовідсотковою. Якщо більша частина населення є імунізованою, поява хворої людини не призведе до епідемії, оскільки її будуть оточувати несприятливі до збудника люди. Так формується колективний імунітет – імунізовані люди захищають неімунізованих (рис. 103). Зменшення кількості вакцинованих людей руйнує колективний імунітет. Із цим пов’язано зокрема ускладнення ситуації з низкою хвороб – поліомієлітом, коровою інфекцією в Україні. Новітні досягнення в галузі імунотерапії. До новітніх досягнень сучасної медицини можна віднести персоналізовану імунотерапію раку. Основним типом імунних клітин, які за нормальних умов знищують чужорідні клітини, у тому числі потенційні ракові, є Т-кілери. Їхня діяльність регулюється різними механізмами, одні з яких скеровані на активацію, а інші — на гальмування. Блокування винайдених нещодавно дослідниками таких
кулярних гальм приводить до розгальмовування, збільшення
таких чинників можна віднести вживання
. Небезпечні звички. Напої, що містять
спирт, люди
культур широко використовують упродовж століть. Тютюн був завезений з Північної Америки у ХVІІ столітті. Однак негативний вплив обох звичок на здоров’я людини давно відомий – це збільшення ймовірності розвитку серцево-судинних патологій, порушень мозкового кровотоку, виразки шлунку, ракових захворювань голови, ротової порожнини, стравоходу, печінки тощо (рис. 104). Уживання алкогольних напоїв є причиною понад 5 % смертей щороку, до того ж найбільша частина припадає на віковий діапазон 20–39 років. Частка смертей від тютюнопаління навіть більша – близько 10 % (рис. 105). Часто високий рівень споживання алкоголю й інтенсивне тютюнопаління спостерігають у тих самих людей, що потенціює негативні ефекти обох чинників. Алкоголь у великих дозах має й негативні соціальні наслідки –нетвереза людина втрачає адекватність поведінки, схильна до ризикованих учинків, які можуть мати сумні наслідки (автомобільні катастрофи, бійки, злочини тощо). Тривале вживання високих доз алкоголю типово супроводжується стійкими соціальними проблемами: хворі на алкоголізм люди втрачають роботу, руйнують стосунки з близькими людьми, можуть учиня-
Рис. 104. Статистичні дані щодо обсягів куріння цигарок і смертності
Рис. 105. Кількість щорічних смертей, викликаних безпосереднім
невтішна: курить
чинають курити у віці до 18 років. Відмова від куріння та вживання великих доз алкоголю є важливими складовими здорового способу життя. Небезпека вживання наркотичних сполук. Небезпечними чинниками, які впливають на здоров’я, є наркотичні сполуки. До них належать як природні, так і штучно синтезовані органічні сполуки різної хімічної природи (рис. 106). Ці сполуки об’єднує здатність суттєво впливати на діяльність нервової системи (збуджувально, седативно, галюциногенно тощо), а також викликати психологічне та фізіологічне звикання. Обіг наркотичних сполук законодавчо заборонений або істотно обмежений. Джерелами природних наркотичних сполук зазвичай є рослини: опійний мак (морфін), коноплі (тетрагідроканабінол), кока (кокаїн) та ін. Фізіологічним механізмом дії більшості наркотичних сполук є активація рецепторів на нервових клітинах, які входять до складу підкріплювальної мозкової системи («центрів задоволення»). За нормальних умов активація таких нейронів відбувається
впливів на наш організм – під час прийому смачної їжі, спілкування з
Nicotiana tabacum
Cannabis sativa
Papaver somniferum
рецептори призводить до зменшення рівня їхньої
шення кількості молекул рецепторів або ж
їхньої
ри, до того ж це відбувається досить швидко. Відтак для досягнення бажаного ефекту стає потрібною щораз більша доза речовини – вона може зростати в десятки разів порівняно з першим прийомом. Зниження активності рецепторів також супроводжується тим, що фізіологічної кількості медіаторів, які виділяються нейронами, стає недостатньо для активації системи винагороди. Тому людині стає складно або неможливо досягти гарного настрою та відчувати позитивні емоції без регулярного прийому наркотичних речовин – формується фізіологічна залежність. Її дуже важко
до нормального стану, оскільки до перебудови діяльності рецепторів залучені генетичні й епігенетичні механізми. Усі
летальну дозу. Процес фізіологічного
речовини
діяльність нервової системи (рис. 108), наркотичні сполуки мають побічні негативні ефекти стосовно діяльності інших систем: погіршення сну, пам’яті, уваги, розвиток емоційних порушень, галюцинації. Збільшується ризик розвитку інсультів та інфарктів, порушень функціонування органів дихання, травлення, нирок тощо. Спільне використання шприців для вживання ін’єкційних наркотиків наражає на небезпеку передавання з кров’ю збудників хвороб. Окрім біологічних наслідків, наркотична залежність спричинює соціальні проблеми: звичайних
для гарного настрою стає недостатньо, висока мотивація знайти
недешевої та забороненої речовини штовхає людину на злочини, втрата адекватності поведінки в стані наркотичного сп’яніння також збільшує ймовірність скоєння протизаконних дій. Дехто вважає, що так звані «легкі» або «клубні» наркотики безпечні для здоров’я. Однак, хоч імовірність передозування такими речовинами менша, втручання в діяльність мозкової системи винагороди у випадку прийому таких сполук також
наслідки. Психоактивні сполуки, що викликають залежність, можуть бути використані як лікарські
4.
ня частоти та глибини дихання, частоти скорочень серця, артеріального тиску тощо. По закінченні роботи кровоносна та дихальна системи повертаються у вихідний стан. Поняття стресу. Зміни умов існування можуть бути дуже сильними або тривалими. У такому випадку розвивається особлива реакція напруження регуляторних систем організму, яку називають стресом. Стреси можуть спричинятися найрізноманітнішими чинниками – стресорами. Особливістю стрес-реагування є його неспецифічність до конкретного характеру стресогенного чинника. За характером чинники можуть бути фізичними (зміни температури, травмування організму), біологічними (дія паразитів), соціально-психологічними (конфлікти, незадоволені потреби). Стадії розвитку стресу. За особливостями змін функціонування організму виділяють три стадії розвитку стрес-реагування (рис. 109). Першу стадію, або реакцію тривоги, характеризують зростання рівня активації
креції адренокортикотропного гормону гіпофізу, що стимулює секрецію корою надниркових залоз адреналіну, ефекти дії якого подібні до симпатичних. Форми стресу. Розрізняють дві основні форми стресу. Еустрес
це реакція організму на помірні за силою подразники. Для нього характерні
тивація описаних вище неспецифічних
механізмів, скерованих на боротьбу з несприятливими чинниками. Еустрес
стадіям розвитку стрес-реакцій. Якщо через
подолано, стрес стає хронічним, а еустрес переходить
повідає стадія виснаження, яку в суб’єктивній сфері супроводжує
сильних негативно-емоційних станів.
дистресів, людина може певною мірою керувати своєю
аналізуючи свої реакції,
Які
існування та поведінки людини. Індивідуальна система поведінки
вона може зберегти здоров’я, гармонійно розвиватися,
працездатність і психоемоційну рівновагу. ! Здоровий спосіб життя (ЗСЖ) – сукупність складників поведінки людини, що сприяє збереженню та зміцненню здоров’я (рис. 111). Важливим є розуміння принципів здорового способу життя – положень, якими керується людина для збереження та зміцнення здоров’я.
Раціональне харчування. Здорове харчування підвищує стійкість людини до інфекційних і паразитарних захворювань, а також істотно знижує ризик виникнення неінфекційних захворювань, зокрема діабету, ішемічної хвороби серця, інсульту та онкологічних захворювань.
Конкретний склад продуктів харчування оптимального раціону може істотно варіювати залежно від індивідуальних особливостей, як-от: вік, стать, спосіб життя, культурні особливості та харчові звички. Проте загальні принципи раціонального харчування є спільними: забезпечення енергетичного балансу; задоволення потреб організму
їжі є білки, жири та вуглеводи, співвідношення між якими за масою приблизно має становити відповідно 1 : 1 : 4. У раціоні не повинно бути багато насичених жирів, а використання транс-жирів (наприклад у маргарині) треба уникати зовсім. Тваринні жири краще замінити на рослинні олії. Прості вуглеводи (моно- та дисахариди) мають становити до 10 % (а оптимально до 5 %) сумарної калорійності – це знизить ризик виникнення серцево-судинних хвороб, карієсу, надмірної ваги тощо. Крім перелічених сполук, добовий раціон повинен містити інші необхідні сполуки, наприклад вітаміни. Контроль кількості харчової солі, добова доза якої не повинна перевищувати 5 г, сприятиме профілактиці гіпертонічної хвороби та інших серцево-судинних патологій. Із методів приготування краще обирати варіння або готування на пару, ніж смаження (рис. 112). Рухова активність і загартовування. Уже йшлося про те, що підвищення адаптаційних можливостей організму людини можливе за рахунок рухової активності й загартовування (§ 5),

звичай жінки та
є менш фізично активними,
чоловіки та хлопці, а люди похилого віку менш активні за молодих. Першочерговим ефектом фізичних тренувань, зрозуміло, є збільшення розмірів, сили та витривалості скелетних м’язів. М’язові волокна не здатні до поділу, тому механізмом росту м’язів є збільшення кількості міофібрил (гіпертрофія, § 4). Фізична активність, окрім власне м’язів, покращує функціональний стан серцево-судинної та дихальної систем, зміцнює кістки, зменшує ймовірність зламати їх при падінні (та й імовірність упасти). Варто зауважити, що під руховою активністю розуміють не лише цілеспрямовану фізкультуру або спорт (відвідування тренажерних залів чи басейнів), а й будь-яку активність, що пов’язана з роботою м’язів – активні ігри, ходіння, катання на велосипеді, хатні, садові, городні роботи, танці тощо (рис. 113). Будь-яка рухова активність, незалежно від мети (робота, навчання чи просто задоволення), є корисною для здоров’я. Необхідний рівень рухової активності є індивідуальним і залежить від стану організму. Для шкільного віку рекомендованим є мінімум у 60 хв активної діяльності. Для дорослих людей відправною точкою може бути щоденне проходження 8000 кроків. Існує чимало
школи, університету або місця роботи. Та для цього, окрім наявності у вас велосипеда, потрібна певна інфраструктура: безпечні та комфортні велосипедні смуги на дорогах, місця для паркування тощо. Школи, університети, робочі місця в ідеалі повинні бути обладнані місцями для занять фізкультурою. Відповідне планування громадського простору населених пунктів, особливо великих міст, матиме в довготривалій перспективі позитивний ефект на громадське здоров’я. Дотримання режиму дня. Важливим принципом здорового способу життя є дотримання режиму дня. Це зумовлено існуванням добової ритміки змін характеру функціонування різних систем організму. Вони визначаються як внутрішніми (вродженими, генетичними), так і зовнішніми (зміни рівня освітленості) чинниками (§ 15). Невід’ємною частиною нормального добового ритму є сон. Добова потреба в ньому є досить індивідуальною в межах вікової норми (рис. 114). Варто пам’ятати, що недосипання є чинником розвитку стресу. Для якісного сну необхідно
тримання правил особистої
та зміцнення здоров’я
шкірою, волоссям, а також одягом і взуттям (рис. 115). Гігієна організму пов’язана передусім з підтриманням чистоти покривів. Дотримання правил гігієни запобігатиме розвитку на шкірі та слизових оболонках інфекційних агентів, передачі деяких внутрішніх та зовнішніх паразитів. Важливим є дотримання гігієнічних вимог до одягу та взуття, особливо в період росту та формування організму (дитячий та юнацький вік). Психічна рівновага та саморозвиток. Важливим для збереження здоров’я є підтримання комфортного психоемоційного стану, що забезпечується уникненням стресових ситуацій, позитивним мисленням, умінням переключатися між роботою та відпочинком, наявністю хобі, постійним творчим та особистісним розвитком тощо. З попередньо вивченого ми дійшли висновку, що істотний негативний вплив на здоров’я чинять наркотичні сполуки, тютюнопаління, надмірне вживання алкоголю тощо. Зрозуміло, що уникнення перелічених шкідливих звичок є обов’язковим елементом здорового способу життя. Важливо слідувати настановам сучасної науки: вчасно проходити профілактичну вакцинацію
Рис. 115.
1.
2.
3.
4.
5.
6.
Практична
захворювань
Мета:
1.
поширеними та небезпечними в Україні? За допомогою інтернет-джерел знайдіть офіційну статистику.
2. Оберіть по одній хворобі з груп: інфекційні, паразитарні, неінфекційні. Ознайомтеся із інформацією щодо їх причин, симптомів і способів лікування. Які засоби профілактики цих хвороб пропонуються сучасною медициною?
3. Що спільного й відмінного в підходах до профілактики інфекційних, паразитарних та неінфекційних хвороб?
4. Ознайомтеся з календарем щеплення в Україні. Перевірте відомості стосовно власної вакцинації та ваших рідних. Чи достатньо ви захищені від відповідних хвороб?
Виконуючи роботу, пам’ятайте, що діагностика хвороб, визначення методів лікування та профілактики повинні здійснюватися фахівцями. Самолікування є небезпечним для здоров’я!
Джерела офіційної інформації:
• https://www.who.int/ – сайт Всесвітньої організації охорони здоров’я
• http://moz.gov.ua/ – сайт Міністерства охорони здоров’я України
1. На основі вивченого матеріалу складіть
вашого здоров’я:
• оцініть якість середовища існування, питної води, повітря
• наскільки ваш раціон відповідає принципам раціонального харчування?
• чи достатній рівень вашої щоденної фізичної активності?
• чи достатньо ви відпочиваєте, наскільки повноцінним є щоденний
Індивідуальне завдання
Сучасна
Ознайомтеся з інформацією: «Нобелівська премія в галузі фізіології або медицини 2018 року була вручена Джеймсу Еллісону й Тасуку Хондзьо за відкриття терапії раку, що полягає в гальмуванні негативної імунної регуляції. Відкритий нобеліантами механізм можна спрощено пояснити на такому прикладі. Т-лімфоцити (ТЛ) мають у складі своїх мембран білок
PD-1 (відкритий та досліджений Тасуку Хондзьо). У разі
активації цей білок ініціює програмовану загибель клітин, або апоптоз. Це зумовлює назву білка Programmed Сell Death 1. У нормі цей механізм потрібен для обмеження імунної відповіді та запобігання розвитку аутоімунних реакцій. Відомо, що деякі ракові клітини (РК) синтезують білок PD-L1, який активує PD-1. Відтак ракові клітини знижують активність Т-ліфмоцитів, які гірше атакують ракові клітини (пунктирна стрілка на рисунку). Це один з механізмів, через які імунна система дає змогу розвинутися раку. Дослідники припустили, що виключення активності білка PD-1 може спричинити протилежний ефект. Вони розробили антитіла до обох зазначених білків (Anti-PD-1 та Anti-PD-L1). Виявилося, що введення в
організм таких антитіл супроводжує
підвищення активності Т-клітин, які інтенсивніше атакують ракові (не-
перервна стрілка на рисунку), що призводить до їх знищення та руйнування
пухлин.»
Завдання 1. Яке з поданих тверджень можна сформулювати на основі аналізу наведеної інформації?
А запрограмовану загибель клітин називають мітозом Б білок PD-1 виконує рецепторну
Індивідуальне завдання Малярія
Малярія є однією з найнебезпечніших хвороб сучасності. За даними ВООЗ щороку ця хвороба реєструється у 91 країні та уражає понад 200 млн людей.
Збудником малярії є одноклітинний еукаріотичний організм з роду Plasmodium. Його переносником є ма-
лярійні комари з роду Anopheles. Малярія виявляється регулярними нападами лихоманки. Перші симптоми з’являються через 10–15 днів після укусу інфікованим комаром. Якщо не
Регіон
Африка427378315246 Америки4026169
Східне Середземномор’я 59492018 Європа2840.10
Південно-східна Азія 44423323
Тихоокеанський11654 Табл. Кількість випадків малярії на 1000 людей у різних регіонах світу.
почати лікування у перші 24 години, перебіг хвороби може бути важким, що може призвести до смерті. Найбільш ефективним шляхом профілактики хвороби є боротьба з комахами-переносниками: використання протимоскітних сіток та застосування інсектицидів. Не менш важливим є лікування людей, що захворіли. Традиційними
Тестові
1. Наука, яка вивчає спадкові захворювання
А гігієна
Б психологія
В антропологія
Г медична генетика
2. Відкриття та застосування яких речовин дозволило
смертність, викликану інфікуванням хвороботворними бактеріями?
А ферментів
Б гормонів
В вітамінів
Г антибіотиків
3. Є спадкові захворювання,
хворювання можна
А синдром Дауна
Б гемофілію
В дальтонізм
Г грип
4. Вчасна
А СНІД
Б гемофілію
В туберкульоз
Г фенолкетонурію
5. Специфічний гуморальний
А фагоцитів
Б лізоциму
В інтерферонів
Г імуноглобулінів
6. Статевим шляхом може передаватися
А грип
Б малярія
В гепатит В
Г сонна хвороба
Тестові завдання з однією правильною відповіддю (1 бал)
7. Проаналізуйте твердження щодо неспецифічного гуморального імунітету. І. Його
що до деяких захворювань людина
схильність, але під впливом умов середовища
висловила правильне судження? А лише перша Б лише
Мономерами білків є
1 жирні кислоти
2 амінокислоти
3 нуклеотиди
Удосконалення профілактики інфекційних захворювань стало можливим унаслідок
1 відкриття антибіотиків
2 винайдення томографів
3 розроблення системи водопостачання будинків
Імпульс розвитку генетики й молекулярної біології надало
1 використання вакцин
винайдення анестезії
використання рентгенівських
уковець вивчав
життям. Артур Тенслі (1871–1955) – британський ботанік, якого вважають
танічних термінів»
(1926).
§ 24.
Екологія як
Які рівні організації живого вам відомі?
Які середовища існування вам відомі?
Що таке адаптація?
Американський еколог і зоолог Юджин Одум, автор класичної праці «Екологія» дав найкоротше означення екології. Він зазначав, що екологія – це біологія навколишнього середовища (рис. 116).
Поняття екології. Термін «екологія» (від грец. oikos – житло, оселя і logos – наука, вчення) запровадив німецький природодослідник і філософ Ернст Геккель 1866 року в праці «Загальна морфологія організмів» для позначення біологічної науки, що вивчає взаємозв’язки організмів з навколишнім середовищем. ! Екологія – наука, що вивчає взаємозв’язки організмів та їх угруповань між собою та з навколишнім середовищем, структуру та функціонування надорганізмових систем. Предмет вивчення та завдання екології. Екологія вивчає закони та закономірності взаємодії організмів й надорганізмових біологічних систем між собою та з навколишнім середовищем; особливості структури, функціонування, формування, розвитку популяцій та екосистем; функції популяцій, екосистем і біосфери. Дослідження в цій галузі біологічної науки вможливлюють розкриття механізмів адаптації організмів, популяцій, екосистем до біотичних, абіотичних
• застосування екологічних знань в охороні
та раціональному використанні природних ресурсів. Виконання цих завдань уможливить перехід до постіндустріального, інформаційного суспільства.
Структура екологічної науки. Наразі виділяють три основні розділи екології: біоекологія, геоекологія та прикладна екологія. Загальна екологія, або біоекологія, – вивчає взаємозв’язки біологічних систем різних рівнів із середовищем і між собою. Цей напрям екології своєю
поділяють на такі підрозділи: аутекологія вивчає закономірності взаємозв’язків організмів окремого виду з середовищем існування (рис. 117); демекологія, або екологія популяцій, вивчає популяції окремих видів (рис. 118); синекологія, або екологія угруповань, аналізує взаємозв’язки між особинами, що належать до різних видів угруповання організмів, а також між ними й середовищем існування (рис. 119); біосферна екологія досліджує процеси, що протікають у біосфері (біогеохімічні цикли, забруднення атмосфери тощо), і зміни, що відбуваються в результаті господарської діяльності людини. Геоекологія вивчає геосфери, їх динаміку й взаємодії, геофізичні умови життя, абіотичні чинники, що діють на організми.
підходу, спостережень, експерименту та
виділяють декілька груп методів. Методи реєстрації параметрів і оцінки стану навколишнього середовища – необхідна частина будь-якого екологічного дослідження. До цих методів належать метеорологічні спостереження, вимірювання вологості, температури, освітленості, хімічного складу повітря, води та ґрунту, оцінювання техногенного забруднення навколишнього середовища, вимірювання радіаційного фону тощо. До цієї групи методів належать також моніторинг (періодичне або безперервне стеження за станом екологічних об’єктів та якістю середовища) й біоіндикація (використання для контролю якості середовища особливо чутливих до чинників екологічного середовища організмів та угруповань) (рис. 120). Методи кількісного обліку організмів, оцінювання біомаси та продуктивності. Ці методи лежать в основі вивчення природних угруповань. Для цього застосовують підрахунки кількості особин на контрольних ділянках, в об’ємах води, повітря та ґрунту; виловлювання й мічення тварин; спостереження за їхніми переміщеннями; аерокосмічну реєстрацію чисельності стад тощо (рис. 121).
Методи дослідження впливу чинників середовища на організми – найрізноманітніша група екологічних методів. Такі дослідження здійснюють за допомогою спостереження в природі та проведення експериментів у лабораторних
що
визначити кількість органічної речовини, яка переходить від однієї ланки трофічного ланцюга до іншої. Особливе значення має експериментальна методика створення та дослідження штучних екосистем (рис. 122, б). Методи моделювання передбачають побудову та використання моделей в екології, що забезпечує можливість прогнозування динаміки розвитку біологічних систем. Це особливо важливо, якщо екосистема піддається зовнішнім, антропічним впливам. Прийоми моделювання дозволяють будувати обґрунтовані прогнози глобального розвитку. Зв’язок екології з іншими науками. Екологія має зв’язок з іншими біологічними науками. Це, наприклад, фізіологія, цитологія, генетика, біофізика, теорія еволюції. Відтак у науці сформовано багато синтетичних напрямів (екологічна фізіологія, еволюційна екологія тощо).
Екологія тісно переплетена з небіологічними науками – фізикою, хімією, геологією, географією тощо. Екологічний підхід до розв’язання географічних і фізико-географічних проблем якнайкраще застосовано в гідробіології: вивчення сукупності організмів, які населяють товщу
дослідженнями різних чинників
2.
3.
Екологічні чинники
Назвіть екологічні чинники.
Поясніть вплив екологічних чинників на біологічні системи.
Ви вже могли впевнитися, що кожний організм тісно пов’язаний і значною мірою залежить від середовища, що його оточує, хоча й сам впливає на нього. Вплив середовища на організми зазвичай оцінюють через окремі чинники. Екологічні чинники. Організм як складник
ньому середовищі перебуває під одночасним впливом різних чинників, які сукупно називають екологічними. ! Екологічні чинники – це всі складники навколишнього середовища, що впливають на стан і властивості організмів та їхніх угруповань. Залежно від природи й особливостей їх поділяють на групи: абіотичні, біотичні та антропічні. Абіотичні чинники – це складники та властивості неживої природи, які прямо чи опосередковано впливають на окремі організми та їхні угруповання. Ці чинники поділяють на чотири групи. Кліматичні – це всі чинники, які формують клімат і здатні впливати на життя організмів (світло, температура, вологість, атмосферний тиск тощо). Властивості ґрунту, які мають вплив на життя організмів, утворюють групу ґрунтових чинників. Орографічні чинники – це вплив характеру рельєфу на життя організмів (висота місцевості над рівнем моря, широта
(рис. 123).
Світло – глобальний кліматичний чинник
Висота місцевості над рівнем моря – орографічний чинник
чинник – вода у твердому
впливу їх
Чинники прямого впливу – це безпосередня дія людини на організм (скошування трави, вирубування лісів, відстрілювання тварин, виловлювання риби тощо). Вплив людини, зумовлений негативними або позитивними наслідками її господарської діяльності, відносять до чинників непрямого впливу (рис. 125). Загальні закономірності дії чинників навколишнього середовища на організми. Незважаючи на різноманітність екологічних чинників, у характері їх впливу на організм і в реакціях живих істот у відповідь можна виділити деякі закономірності, які є значною мірою універсальними стосовно організмів. Результатом узагальнення багатьох досліджень у цій галузі є розкриття однієї
оптимуму. Відповідно до цього закону для організму
найбільш сприятливого (оптимального) значення чинника. Сприятливу силу впливу називають зоною
124. Біотичні чинники
125. Антропічні чинники
Чинник прямого впливу – вирубу-
потомство, тобто є найбільш пристосованими до умов середовища. Внутрішньовидова конкуренція особин популяції зайців за кормову базу
Рис.
Рис.
називають межами витривалості або межами толерантності. Життєдіяльність
описують куполоподібною кривою (рис. 126). Здатність видів адаптуватися до того або іншого діапазону чинників середовища називають екологічною пластичністю виду, тобто здатністю організмів пристосуватися до змін умов навколишнього середовища. Кількісно екологічна пластичність охоплює діапазон значень чинника від нижнього екологічного мінімуму на шкалі чинника до верхнього екологічного максимуму. Що ширший діапазон коливання чинника, у межах якого цей вид може існувати, то більша його екологічна пластичність і то ширші
тривалості (§ 5).
Описана закономірність ґрунтується на відкриттях, які були зроблені природодослідниками в кінці ХІХ та на початку ХХ століття. Історично першим для екології є закон мінімуму, сформульований німецьким ученим Юстусом фон Лібіхом 1840 року. Цей закон установлює залежність біологічних систем від чинників, які обмежують їхній розвиток – лімітувальних чинників: якщо кількість і якість екологічних чинників близькі до мінімуму, необхідного для організму, він виживає, якщо менші
кість екосистеми знижується (рис. 127).
мального значення
30°С, а тропічні корали гинуть уже за
температури на 5–6 °С. Швейцарський природодослідник Едуард Рюбель
кон взаємокомпенсації чинників: відсутність
встановив
нестача деяких екологічних чинників може бути компенсована іншим близьким (аналогічним) чинником. Наприклад, нестача світла для рослини
бути компенсована надлишком вуглекислого газу в повітрі. Світло є необхідним для
автотрофного процесу рослинних організмів – фотосинтезу. Підвищена концентрація
чається до складу органічних сполук. Однак
реакції, у
можливості надзвичайно обмежені. За умови повної відсутності світла фотосинтез не зможе відбуватися зовсім навіть за найсприятливіших інших
екологічних чинників має значення закономірність, яку називають
незамінності фундаментальних чинників
відсутність у середовищі фундаментальних екологічних чинників (світла, води тощо) не може бути замінена іншими чинниками. Пригадавши
1. Дайте
2.
3.
5.
фон
використовував діжку для ілюстрації закону (модель називають діжкою Лібіха). Так само як об’єм діжки, виготовленої з нерівних дощечок, обмежений найменшою дощечкою, так і ріст рослини та її врожайність обмежуються поживною речовиною, наявною в найменшій кількості.
Поняття
Що таке біологічний вид?
Що таке екологічна ніша?
Вам відомо, що одиницею
цію. Цієї думки притримуються також сучасні науковці.
Поняття популяції. Біологічний
тку пристосовується до певних умов існування, що визначає межі його поширення (ареал). У межах поширення виду його особини живуть сукупностями – популяціями. Наявність популяцій у природі пов’язана з неоднорідністю умов існування на території, що її займає вид. Що більш різноманітними є умови існування в ареалі виду, то більшою є кількість популяцій, із яких він складений.
Популяція – сукупність особин виду, яка займає частину території його поширення й ізольована від
з представниками інших популяцій, оскільки всередині популяції схрещування відбувається значно частіше (рис. 128).
Характеристики популяції. Популяцію характеризують такі основні показники: площа або об’єм, чисельність, щільність, народжуваність, смертність, приріст. Популяція в екосистемі займає певну площу або об’єм. Чисельність популяції – кількість особин
(води, повітря, ґрунту),
Структура популяції. Унаслідок взаємодії популяції з навколишнім середовищем формується її структура. Структура популяції є формою адаптації до умов її існування, своєрідним віддзеркаленням екологічних чинників, що на неї впливають. Виділяють статеву, вікову, просторову й етологічну структуру популяції. Статеву структуру популяції визначає співвідношення особин різних статей, а вікову – розподіл її особин за віковими групами. Скорочення частки статевонезрілих особин свідчить
популяції в майбутньому, коли ці особини залишать нечисленне потомство. Просторова структура популяції – це особливості поширення особин популяції на території, яку вона займає. Залежно від характеру використання території, популяції тварин поділяють на осілі (наприклад, кроти), кочові (шпаки, песці) та мігруючі (перелітні птахи, лемінги) (рис. 129). Зв’язки між особинами, що виявляються в їхній поведінці, зумовлюють етологічну структуру популяції. Є організми, що ведуть поодинокий спосіб життя, наприклад скорпіони. Натомість коралові поліпи утворюють колонії, олені – стадо, а вовки – зграї , тож ці тварини ведуть груповий спосіб життя (рис. 130). При цьому
ність популяцій організмів, що мешкають навіть у стабільних умовах, можуть змінюватися під впливом різноманітних чинників. ! Популяційні хвилі – це періодичні або неперіодичні коливання чисельності популяцій у природних умовах.
Чисельність популяції залежить від інтенсивності народжуваності та смертності особин, різниця між якими визначає її приріст. Якщо інтенсивність народжуваності перевищуватиме смертність, то приріст популяції буде позитивним, якщо навпаки – негативним. Негативний приріст популяції протягом тривалого часу може призвести до її зникнення. За низької щільності, коли умови середовища сприятливі, народжуваність перевищуватиме смертність. Якщо щільність популяції стає вищою або нижчою від певного рівня, у ній виникають процеси саморегуляції, що виявляється у вигляді популяційних хвиль. Щільність популяцій залежить у тому числі і від абіотичних чинників, насамперед від кліматичних. До змін вологості та кількості сонячної радіації дуже чутливі, наприклад, однорічні рослини та пойкілотермні тварини. На зміни в чисельності популяції також впливають біотичні чинники. Наприклад, чисельність популяцій хижаків залежить від популяції здобичі, а чисельність популяції паразитів – від популяції організмів, у яких вони паразитують.


Унаслідок
або збільшення чисельності особин частота зустрічальності тих чи інших алелів у генофонді популяції може змінюватися. Наприклад, зменшення
ті їжі неврожайного року спричиняє зменшення чисельності популяції вивірки, що може випадковим чином призвести до зміни частоти зустрічальності алелів, які визначають забарвлення хутра (рис. 132). Такі випадкові зміни генофонду популяції називають дрейфом генів. Популяційні хвилі та дрейф генів є елементарними факторами еволюції, з якими ви знайомилися в 9 класі. Класифікація популяцій. Існують різні підходи до створення класифікацій популяцій. Відомий еколог Микола Наумов запропонував виокремлювати популяції залежно від розмірів території, яку вони займають: елементарна, екологічна та географічна популяції. Елементарна популяція – це сукупність особин виду, що населяють ділянку однорідної площі (кількість таких популяцій пропорційна різноманіттю умов екосистеми). Екологічна популяція – це сукупність елементарних популяцій,
певні екосистеми, наприклад грабові бучини. Географічна популяція – це сукупність груп особин попереднього рангу, що заселяють
(генотип бука: рахівський, кам’янець-подільський
Поняття екосистеми
Що таке угруповання організмів?
Які рослинні угруповання ви знаєте?
Які організми називають автотрофами, гетеротрофами та міксотрофами?
Ви вже знаєте, що популяції різних видів пов’язані не лише між собою, а й з умовами середовища існування. Угруповання організмів утворюють з навколишнім середовищем єдине ціле – екосистему. Поняття екосистеми та її структура. ! Екосистема – це сукупність організмів різних видів, які взаємодіють між собою і з середовищем у такий спосіб, що всередині системи відбуваються перетворення енергії, колообіг речовин і саморегуляція. У структурі будь-якої екосистеми розрізняють абіотичну (умови середовища існування) та біотичну (сукупність взаємопов’язаних організмів) частини (рис. 133).
До абіотичної частини належать: неорганічні сполуки (кисень, вуглекислий газ, азот, вода тощо), органічні сполуки (рештки організмів і продукти їхньої життєдіяльності), мікроклімат (середньорічна температура, вологість тощо).
Біотичну частину становлять популяції
з різним типом живлення: продуценти – автотрофні організми (рослини, хемотрофні прокаріоти); консументи – гетеротрофні організми, які живляться іншими організмами, соками цих організмів або їхніми рештками (рослиноїдні тварини, хижаки, паразити); редуценти
гетеротрофні організми, які живляться залишками
Характеристики екосистем. Будь-якій екосистемі притаманні видове різноманіття, щільність популяцій, біомаса, біологічна продуктивність, площа та об’єм, які займає екосистема. Розгляньмо ці характеристики докладніше.
Видове різноманіття передбачає два основні компоненти – видове багатство та рівномірність. Видове багатство визначається кількістю
екосистемі. Інколи його виражають відношенням кількості видів до
площі. Рівномірність показує співвідношення розподілу
екосистемі.
Щільність популяцій
(тварин, рослин, мікроорганізмів) у розрахунку на одиницю об’єму (води, повітря або ґрунту) або поверхні (ґрунту або дна водойми) (рис. 134).
Біомаса – одне з найважливіших понять екології, яке означає загальну масу сирої або сухої органічної речовини екосистеми, що припадає на одиницю поверхні або об’єму місця існування. Серед екосистем найбільшу біомасу мають тропічні ліси. Серед гетеротрофних організмів найбільшу масу
твореної організмами
організмів і популяцій, які до неї входять. Вона виявляється в їхній здатності до збереження в несприятливих умовах. Отже, основою стійкості організмів є їхня здатність до адаптації.
Здатність до самовідтворення зумовлена здатністю популяцій організмів, які входять до складу екосистеми, відтворювати свою чисельність, а також брати участь у регуляції чисельності популяцій інших видів.
Саморегуляція екосистем полягає в коливаннях показників їхньої продуктивності і потоків енергії навколо оптимальних значень. Основні біоми Землі. Біосфера, як глобальна екосистема, складена з наземних, водних та, з огляду на сучасний стан, штучних екосистем. Усі пов’язані між собою екосистеми однієї природно-кліматичної зони входять до складу біома.
гості, тому різняться за типами рослинності, але часто з урахуванням висоти над рівнем моря. Одну з класифікацій
відтворено на карті (рис. 135).
Рис. 135. Наземні біоми Землі
(річки, потоки) та болота. До морських біомів належать, наприклад, пелагіаль (відкритий океан), континентальний шельф (прибережні води), літораль (зона узбережжя дна), естуарії (прибережні бухти, проливи, гирла рік тощо). Розгляньмо особливості біомів, розташованих у межах території України. Виділяють декілька основних типів наземних біомів. Це, наприклад, листопадні ліси, степ, гірські ліси (Карпати) та субтропічні сухі ліси (Південне узбережжя Криму). Листопадні ліси нашої країни формуються в помірному поясі в умовах достатньої вологості. Середньорічна сума опадів становить 600 – 700 мм. Степи України теж формуються в помірному поясі
умовах
ливого клімату. Опадів випадає на рік від 250 до 750 мм. Гірські ліси Карпат формуються в помірному поясі в умовах достатньої вологості. Середньорічна сума опадів становить 650 – 750 мм. Субтропічні сухі ліси Південного узбережжя Криму є своєрідним біомом. Вони формуються на вузькій ділянці суходолу між Чорним морем і Кримськими горами в умовах унікального клімату, так званих «північних субтропіків», де середньорічна сума опадів становить не більше 600 мм на рік (рис. 136). Штучні екосистеми людина створює для власних потреб. Метою створення може бути вирощування рослин, які людина використовує в їжу (поля, сади), захист ґрунтів (лісосмуги). Такі штучні екосистеми можуть сприяти зниженню рівня шуму
3.
5.
Що таке популяція?
Що таке симбіоз, мутуалізм, коменсалізм, паразитизм, хижацтво?
Як вам відомо, популяції різних видів пов’язані не лише між собою,
з умовами середовища існування. Угруповання організмів утворюють з навколишнім середовищем єдине ціле – екосистему. Структура екосистеми підтримується за рахунок різноманітних зв’язків між популяціями. Залежно від характеру потреб виділяють чотири типи
різних видів в екосистемах: трофічні, топічні, форичні та фабричні. Трофічні зв’язки. Ці зв’язки виникають тоді, коли організми одного виду живляться організмами іншого (живими особинами, їхніми рештками або продуктами їхньої життєдіяльності). Функціонування екосистеми пов’язане з перетворенням енергії. Основним джерелом енергії
зв’язків
реважна частина яких є фотосинтезувальними рослинами. На другому рівні знаходяться рослиноїдні тварини та інші організми, що живляться продуцентами, – це консументи І порядку. Хижаки і паразити формують рівень консументів ІІ та вищих порядків.
ми, або редуценти,
тритний).
Трофічний ланцюг, що починається
хемотрофних організмів, називають пасовищним, або ланцюгом виїдання. Приклад ланцюга виїдання – взаємовідносини між організмами
із квіткової рослини.
метелик, що живиться нектаром квітки. Метелика поїдає мешканець вологих місць існування – жаба. Її захисне забарвлення дає їй
ву, але не рятує від іншого хижака – вужа.
цей ланцюг живлення. Трофічний ланцюг, що
відмерлих залишок рослин,
й екскрементів тварин, називається детритним, або ланцюгом розкладання. Він починається з розкладання мертвої органічної речовини й
ється сапротрофами (членистоногі, черви, гриби та мікроорганізми), які
безпосередньо споживають.
клад комахи).
ланцюга (рис. 139).
Розрізняють три типи екологічних пірамід: піраміда чисел, що відображає співвідношення між кількістю особин на кожному трофічному рівні; піраміда біомаси (кількість органічної речовини, синтезованої на кожному з рівнів); піраміда енергії (величина потоку енергії). Завдяки правилу екологічної піраміди можна оцінити кількість речовини й енергії на кожному з трофічних рівнів. Топічні зв’язки. Ці зв’язки виникають тоді, коли види не пов’язані прямими трофічними зв’язками, але внаслідок життєдіяльності одних видів змінюються умови існування інших. Часто представники одних видів мешкають на поверхні тіла інших. Наприклад, ракоподібні оселяються на шкірі китів, а орхідеї – на стовбурах дерев, у пір’ї птахів мешкають блохи, кліщі, клопи, а у внутрішніх органах і м’язах – паразитичні черви тощо. Прикладом топічних зв’язків також слугує ярусність рослинних угруповань. У лісі створюється свій мікроклімат, який характеризується підвищеною вологістю, малою контрастністю температур, меншою освітленістю. Це сприяє росту рослин і розміщенню
які займають різні
Рис.
дові взаємозв’язки, які становлять основу їх існування. Форичні зв’язки. Це зв’язки, за яких особини одного виду беруть участь у поширенні особин іншого виду. Вам добре відомі тварини, що переносять насіння, спори, пилок рослин. Це різноманітні ссавці, птахи та комахи. Наприклад, великі ссавці – олені, лосі – сприяють поширенню плодів і насіння рослин, розселення паразитів на тілі цих тварин. Насіння лопуха, що має гачечки, може чіплятися до шерсті ссавців і переноситися на великі відстані від місця його оселення (рис. 140). Фабричні зв’язки. Це зв’язки, за яких особини одного виду використовують для своїх споруд (гнізд, схованок) продукти виділення, рештки або навіть організми іншого виду. Наприклад, птахи будують гнізда із сухих гілок, трави, пір’я інших птахів, шерсті тварин. Бобри беруть гілки дерев для будівництва своїх хаток (рис. 141). Личинки волохокрильців для створення своїх осель використовують уламки або навіть цілі мушлі з живими
ками дрібних видів. Отже, між популяціями різних видів, що входять до складу екосистеми, виникають складні та різноманітні
Їхня сукупність
функціонування екосистеми як цілісної системи та її саморегуляцію. Стабільність екосистеми, безумовно, залежить
відповідь на зміни екологічних чинників. Причини змін екосистем. Усі екосистеми є середовищем
виявів природного добору. Взаємозв’язані в екосистемі види завжди впливають і на абіотичні компоненти середовища. Це, своєю чергою, спричиняє зворотний вплив
чинників на живі компоненти екосистем. Постійна взаємодія всіх компонентів спричиняє зміни екосистем.
зміни компонентів екосистеми. Поступальні
ся, наприклад, у результаті
пово перетворюється на мілке, потім
болото (рис. 142), а іноді
на глинах після відступу льодовика або проходження селю.
Доречно розглянути послідовність утворення первинної сукцесії на скельних породах помірних широт, наприклад в Україні. На них насамперед оселяються лишайники, що майже не потребують поживних речовин і здатні прикріплюватися до каміння. Відтак на це місце вітер переносить частинки ґрунту, що є передумовою для появи різних
з’являються трав’янисті рослини, що сприяють поступовому формуванню ґрунтового покриву. Наступним етапом
цієї території різноманітними видами верб і утворення чагарникових угруповань. У цей період тваринний світ представлений переважно безхребетними тваринами (червами, комахами, молюсками). Надалі починають поступово з’являтися хвойні рослини (сосна, ялина, модрина), утворюються хвойні ліси, які
хребетними тваринами. Зрештою
шані ліси (рис. 143).
Рис. 143. Первинна сукцесія
зниженням чисельності й продуктивності організмів. Причиною їх виникнення є вплив господарської діяльності людини на навколишнє середовище. Так, в Україні Азовське море, що було однією із найпродуктивніших морських водойм, наразі стало зоною екологічної катастрофи.
Закономірності здійснення сукцесій. Під час сукцесії збільшується видове різноманіття. Це призводить до ускладнення зв’язків, розгалуження трофічних ланцюгів, ускладнення трофічної сітки і зрештою до збільшення стабільності екосистеми. Відбуваються також перетворення в її енергетичному балансі. Загальна біомаса екосистеми спочатку інтенсивно зростає, а потім темпи цього зростання знижуються. На стадії клімаксу біомаса екосистеми стабілізується. На перших етапах розвитку сукцесії продуктивність екосистеми відносно висока. У сформованих, стійких екосистемах майже весь приріст рослинності надходить і витрачається в ланцюгах живлення гетеротрофними організмами, тому продуктивність екосистеми наближається до нуля. Ці закономірності характерні для екосистем будь-яких розмірів: від лісової галявини до біосфери. Стабільність екосистем. За відсутності
вань завершується формуванням
теми).
зміни клімату або внаслідок дії
верження вулкана. Існують сталі клімаксні екосистеми, не змінені катастрофічними чинниками, у тому числі господарською діяльністю людини. Прикладом можуть слугувати заплава рівнинної річки або діброва, поширені в помірному поясі (рис. 145). Діброва – це ліс, у якому зростає переважно дуб і менш поширені супутні широколистяні породи: клен, липа, ясен, граб тощо. В Україні найцінніші масиви дібров (Чорний ліс, Холодний яр тощо) узяті під охорону як заказники або заповідні урочища. Кожна екосистема характеризується продуктивністю. Під продуктивністю розуміють відтворення біомаси рослин, мікроорганізмів і тварин, що входять до складу екосистеми. Вона залежить насамперед від географічного положення екосистеми. На суходолі найпродуктивнішим біомом є вологі тропічні ліси, а водним – коралові рифи (рис. 146). Найнижчою є продуктивність арктичних і тундрових екосистем. Варто
найбіднішими за біорізноманіттям (рис. 147). Відтворення біомаси
Агроценози, їхня структура та особливості функціонування
Що таке екосистема? Яка структура екосистеми?
Що таке продуценти, консументи та редуценти?
Як вам відомо, розрізняють природні (наземні, водні) (рис. 148) та штучні екосистеми (рис. 149). Прикладами наземних природних екосистем є тундра, тайга, широколистяні ліси, степ, савана, пустеля, тропічні лісі. Водні природні екосистеми – озера, річки, струмки, болота, відкритий океан, прибережні води тощо.
Поняття агроценозу. У підручнику для дев’ятого
лошено, що штучні екосистеми
потреб. Це сади, парки, городи, поля,
родних угруповань вони відрізняються властивостями й особливостями функціонування. Незначне видове різноманіття та
розгалужені трофічні зв’язки зумовлюють
втручання людини
руйнуються
! Агроценоз (від грец. agros – поле, koinos – загальний) – штучна екосистема, створена людиною для своїх цілей шляхом посіву
шого культивування рослин, а також використання території
інтенсивного випасу свійських тварин.
Рис. 148. Приклади природних екосистем (Україна)
Рис.
що й природні: продуценти, наприклад, жито й
консументи, поміж яких комахи, гризуни, а також редуценти – гриби та бактерії (рис. 150). Людина є обов’язковою ланкою харчового ланцюга в будь-якому агроценозі. Вона створює цей агроценоз, забезпечує його високу продуктивність, а потім збирає та використовує врожай. Особливості функціонування агроценозів. На відміну від природних екосистем, для агроценозів характерне невелике видове різноманіття: переважають одна або декілька культур, обраних людиною для вирощування (поле пшениці, жита чи кукурудзи). Відповідно, кількість видів тварин, грибів і бактерій теж є обмеженою. У природних екосистемах діє природний добір, який відкидає неконкурентоспроможні види. За рахунок цього забезпечується стійкість екосистеми. В агроценозах діє переважно штучний добір, спрямований людиною на підвищення врожайності сільськогосподарських культур. Отже, екологічна стійкість агроценозів невелика. Вони не здатні до саморегуляції й самовідтворення, тому без участі людини агроценози зернових



Отже, порівняно з природними
обмежений видовий склад рослин і тварин, не здатні до самовідновлення та саморегуляції, схильні до загибелі в результаті масового розмноження шкідників або збудників хвороб і потребують постійної уваги людини. Шляхи підвищення продуктивності агроценозів. Наразі проводиться меліорація земель – осушення і зрошування ґрунтів, боротьба з ерозією (зміцнення схилів, безвідвальна оранка, висаджування лісосмуг, залуження колишніх торф’яників тощо). Людина застосовує раціональне внесення добрив, дозоване застосування засобів для боротьби зі шкідниками та хворобами рослин і з бур’янами. Сучасні сільськогосподарські виробники створюють агропромислові комплекси, використовують високопродуктивну техніку, виводять нові високоврожайні сорти культурних рослин, стійкі до хвороб і шкідників, застосовують біологічні способи боротьби зі шкідниками. В овочівництві і квітникарстві широко використовують теплиці, парники й вирощування овочів без ґрунту – гідропоніку (як субстрат застосовують гравій, зрошуваний розчинами солей) (рис. 151) та
Рис. 151.
Проект
Дослідження особливостей структури місцевих
екосистем (природних чи штучних) Етапи реалізації проекту
1. Ознайомтеся з літературою й інтернет-ресурсами з цього питання.
2. Ознайомтеся з прикладом опису структури двох місцевих природних екосистем (див. таблицю).
3. Складіть порівняльну характеристику структури двох місцевих природних екосистем (за власним вибором).
4. Сформулюйте висновок про чинники, що впливають на формування структури екосистеми.
Порівняльна характеристика структур екосистем
Частини екосистеми Екосистема заплавної лукиЕкосистема
Абіотична:
середня температура (°С)
січня липня
від –4,0 до –8,0 від +17 до +19
від –4,5 до –8,5 від +17 до +19
вологість650 – 700 мм/рік600 – 700 мм/рік
типи ґрунтів
Біотична :
продуценти
консументи
Дернові, дерново-лучні, болотні
Лукові трави:
Злакові – тимофіївка, мятлик, лисохвіст (нижній ярус)
Бобові – конюшина, горошок, чина (другий ярус) Зонтичні – губоцвіті, жовтоцвіті, гвоздикові (верхній ярус)
Дерново-підзолисті, болотні
Мохи, лишайники (нижній ярус)
Підсніжник, проліска, ряст, анемона (другий ярус) Чагарники – ліщина, глід, черемха, бузина, терен, шипшина (третій ярус)
Найвищі дерева – дуб, сосна, ялина, граб, клен, липа, береза, осика (верхній ярус)
Рослиноїдні тварини: метелики, бджоли, равлики, жайворонок, куріпка, миші, ховрахи, зайці М’ясоїдні тварини, що поїдають рослиноїдних тварин: павуки, їжаки, деркачі, бекаси Хижаки, що поїдають м’ясоїдних тварин: боривітер, яструб, лисиця Детритофаги: мурахи, дощові черв’яки, орлистерв’ятники Рослиноїдні тварини: метелики, бджоли, білки, зайці, дикі свині, козулі, лосі, олені М’ясоїдні тварини, що поїдають рослиноїдних тварин: павуки, їжаки, дятли, горлиці Хижаки, що поїдають м’ясоїдних тварин: лисиці, вовки, ведмеді Детритофаги: мурахи, дощові черв’яки
життєдіяльністю організмів. Межі біосфери та оболонки планети Земля. Біосфера охоплює частину атмосфери до висоти озонового шару (20–22 км), частину літосфери (2–3 км нижче від поверхні) та всю гідросферу (рис. 153). Атмосфера – це газувата оболонка, що оточує нашу планету. Суміш газів, що становить атмосферу, називають повітрям. Поширення організмів в атмосфері обмежене озоновим шаром. Максимальна висота, на якій виявлено спори бактерій і грибів, сягає 22 км. Гідросфера – водна оболонка планети, сукупність океанів, морів, вод континентів, льодовикових покривів. Вода є основою існування життя на

Газову функцію здійснюють зелені рослини, які під час фотосинтезу виділяють в атмосферу кисень; рослини й тварини, які під час дихання виділяють вуглекислий газ; багато видів бактерій, що відновлюють Нітроген зі сполук. Концентраційна функція пов’язана з накопиченням у живій речовині хімічних елементів (Карбону, Гідрогену, Нітрогену, Оксигену, Кальцію, Калію, Силіцію, Фосфору тощо). Окремі види організмів є своєрідними концентраторами деяких елементів (рис. 154).
Окисно-відновна функція виявляється в окисненні речовин за допомогою організмів у ґрунті й гідросфері з утворенням солей, оксидів, а також відновленні речовин. З діяльністю бактерій пов’язане формування вапняків, бокситів, а також залізних, марганцевих і мідних руд. Біохімічна функція здійснюється під час обміну речовин в організмах (живлення, дихання, виділення), руйнування відмерлих організмів і розщеплення продуктів їхньої життєдіяльності. Ці процеси складають колообіг (біогеохімічні цикли) речовин у природі. Жива речовина значно прискорила
процесах, повинні були б уже давно вичерпатись. Однак цього, як ви знаєте, не відбувається. Насправді всі потрібні для підтримання життя речовини не вичерпуються
ганізми в органічну природу. Біогеохімічний цикл у біосфері. Колообіг речовин
винами між абіотичною
Рис. 155. Біогеохімічний цикл води
Надалі рослини поїдаються гетеротрофними організми.
сполуки, синтезовані рослинами, рухаються ланками трофічних ланцюгів. Під час дихання вуглеводи окиснюються. За рахунок вивільнення енергії відбуваються всі життєві процеси, а вуглекислий газ виділяється в повітря. Розкладання відмерлих організмів здійснюється
торф, кам’яне
гілля, нафта, сланці. Людина спалює їх, використовуючи як джерело енергії, і вуглекислий газ також
коло замикається, і розпочинається новий цикл уключення Карбону до складу органічних сполук, що їх синтезують рослини (рис. 156). Біогеохімічний цикл Оксигену. Кисень атмосфери має
дження. Він постійно надходить в атмосферу
час дихання використовують аеробні організми. Одним з кінцевих
завдяки біологічній (бактерії, ціанобактерії), промисловій (виробництво мінеральних добрив) і атмосферній (блискавка) азотфіксаціям. Завдяки цим процесам атмосферний азот перетворюється в нітрати, які можуть засвоюватися рослинами. Іншим джерелом Нітрогену для рослин є розкладання органічних решток, унаслідок чого утворюються сполуки амонію, сечовина та амоніак. Ці сполуки завдяки діяльності нітрифікувальних бактерій також перетворюються в речовини, доступні для рослин. Повернення Нітрогену в атмосферу відбувається внаслідок розкладання сполук, що містять цей елемент, до вільного азоту та кисню ґрунтовими бактеріями. Людина своєю діяльністю значно впливає на колообіг Нітрогену. Систематичне застосування азотних
зумовлює збільшення концентрації сполук Нітрогену в ґрунтах, водах, продуктах харчування (рис. 157). Роль організмів у перетворенні оболонок Землі. Організми беруть участь в утворенні осадових порід, ґрунтоутворенні, підтриманні сталості газового складу атмосфери. Осадові породи виникають на дні водойм унаслідок нашарування різних нерозчинних речовин, значна частина яких має біогенне походження. З решток організмів, які впродовж життя накопичують у своїх скелетах, мушлях, панцирах карбонати, фосфати, силіцій(IV) оксид, утворюються осадові породи (крейда, кремнезем, радіолярити, діатоміти, вапняк). Торф і кам’яне вугілля утворилися
Рис. 157. Біогеохімічний цикл
що руйнують гірські породи.
Унаслідок діяльності різноманітних організмів тривають
ґрунтоутворення: розкладання органічної речовини на мінеральні сполуки, утворення гумусу та його розкладання, розкладання й утворення мінеральних сполук.
Життєдіяльність організмів спричиняє зміну газового складу атмосфери – на початку розвитку біосфери він значно відрізнявся від сучасного. В атмосфері було багато водяної пари, вуглекислого газу, сірководню,
шару. Через це ультрафіолетові промені без перешкод досягали
у водному середовищі, оскільки вода поглинала ці промені.
змінювався: зменшувався вміст вуглекислого газу, метану, амоніаку; утворилися вільний кисень,
них копалин, які природа накопичувала мільйони років, швидко
ся. Ми швидкими темпами використовуємо енергію,
нафті, природному газі, а
Що таке біосфера? У чому полягає антропічний чинник?
датний природодослідник Володимир Вернадський. Це дало йому поштовх до створення учення про біосферу, тобто ту частину зовнішніх оболонок нашої планети, яка безпосередньо пов’язана з існуванням життя на Землі. Вчення В. Вернадського про біосферу. Це вчення є одним з найбільших узагальнень науковця в царині природознавства. Як ви вже знаєте, поняття «біосфера» використовував австрійський геолог
року. Але глибокого наукового змісту
(1863–1945)
Біогенна речовина – продукти, створені
результаті
організмів (кальцит і арагоніт у карстових печерах, кам’яне та буре вугілля, природний газ, нафта, торф тощо) (рис. 161).
Нежива речовина – неорганічні сполуки, в утворенні яких організми участі не брали (деякі гірські породи, мінерали, осадові породи) (рис. 162).
Біокосна речовина – це неорганічні сполуки, утворювані в результаті взаємодії живої та неживої речовини (кисень, ґрунт, мул, сланці тощо) (рис. 163). Друге положення вчення В. Вернадського про біосферу полягає в тому, що він уважав енергію Сонця космічним джерелом енергії в біосфері. Організми перетворюють енергію променів Сонця в хімічну
наміки.
Формулюючи третє положення вчення про біосферу, В. Вернадський відзначав здатність живої речовини постійно зростати, розрахував швидкість можливого заселення поверхні Землі деякими організмами
шкодного існування. Цю особливість
Рис. 160. Жива речовина
Рис. 161. Біогенна речовина
Рис. 162. Нежива речовина
Рис. 163. Біокосна речовина
у
річках та озерах воно дуже різноманітне та щільне (рис. 164). Найбільшу концентрацію живої речовини спостерігають на межі розподілу середовищ існування – у ґрунті як прикордонному шарі між атмосферою та літосферою, у поверхневих шарах океану, на дні водойм і особливо в лиманах, на літоралі, де всі три середовища – ґрунтове, водне й повітряне розташовані поряд. Місця найбільшої концентрації організмів В. Вернадський називав «плівками життя».
Науковець дійшов висновків: біосфера – організована оболонка; бути живим – значить бути організованим (відповідно до ролі й функцій організмів їх поділяють на продуцентів, консументів і редуцентів); для організмів у біосфері характерна їхня геохімічна робота, яка виявляється у формі незамкнутих і незворотних потоків енергії та речовин (біохімічних циклів, оскільки до процесів колообігу долучаються нові організми); біогеохімічна циклічність є суттю організованості й еволюції біосфери. Отже, біосфера – це оболонка Землі, що охоплює всі організми й ту частину речовини планети, яка перебуває в безперервному обміні з цими організмами. Таку цілісну й завершену систему
сьогоднішні
а про майбутні наслідки. ! Ноосфера (від. грец. noos – розум) – це етап розвитку біосфери, за якого людина, свідомо використовуючи свої знання, буде підтримувати існування біосфери та сприяти її еволюції.
Вчення В. Вернадського про ноосферу містить чотири основні положення: ноосфера – історично останній стан геологічної оболонки біосфери, що перетворюється діяльністю людини; це сфера розуму та праці; зміни біосфери зумовлені як свідомою, так і несвідомою діяльністю людини; розвиток ноосфери пов’язаний з розвитком соціально-економічних чинників. Науковець зауважував також, що ноосфера відрізняється від біосфери величезною швидкістю розвитку. Володимир Вернадський – це український філософ і природознавець, засновник геохімії, біогеохімії та радіогеології, вчення про біосферу та ноосферу. Ім’я вченого присвоєно багатьом академічним інститутам, кораблям, бібліотекам, зокрема Національній бібліотеці України. На пошану вченого названо два мінерали «вернадит» і «вернадскит» (рис. 165). У 1996 році заснували українську антарктичну станцію «Академік Вернадський» (рис. 166). Він є одним із засновників Української академії наук та був її першим
зидентом.
Індивідуальне завдання
Корабельний черв’як
Ознайомтеся з інформацією: «За часів активного використання дерев’яних кораблів
них становив організм під назвою корабельний черв’як. Це витягнутої форми тварина, що живиться деревиною, висвердлюючи в ній ходи та наносячи шкоду дерев’яним конструкціям. Тіло корабельних червів зовні вкрито складкою покривів, яка формує порожнину. Через два отвори –ввідний та вивідний сифони – усередину цієї порожнини засмоктується та виводиться назад вода. Її потік постачає
організм як киснем, що поглинається зябрами, так і їжею, яку черв’як відфільтровує з води. Корабельні черви бурять ходи за допомогою невеликої двостулкової черепашки з
кальцій карбонату, розташованої на передньому кінці тіла. Частина цих стулок укрита гострими зубцями, за допомогою яких тварина і вгризається в товщу деревини. Заглиблюючись, корабельний черв’як залишає на стінках ходу захисний вапняний шар. Таке пристосування надихнуло в ХІХ ст. інженера Марка Брюнеля на створення прохідницького щита – машини для риття тунелів у нестійких ґрунтах. З допомогою щита в 1824–1843 роках за проектом Брюннеля був пройдений тунель під Темзою в Лондоні. Корабельні черви мешкають у морях з достатнім рівнем солоності. Саме через активність таких тварин підводним археологам рідко вдається знайти неушкоджені кістяки
збережений корабель шведського військового флоту
жить ця тварина?
кишковопорожнинні
кільчасті
саму глиб лісу. [...] Ти давно чуєш, як межи водяві дерев’яні трелі втручається вищий, чистіший, довший тон. Це друга флейта, флейта-піколо Слобожанської Швайцарії. Ти можеш бачити, який піколо грає на цю флейту. [...] Це золотава щурка, як кажуть, єдиний залишок колишньої тропічної фавни, ще перед великою мандрою льодових полюсів Землі. Дядьки називають цього птаха бджолоїдом, бо він полює залюбки на бджіл. А от над річкою шугнув
королик-рибалка, так
1.
вологості повітря після
Г виділення фітонцидів у повітря
2. Дослідники виявили вплив біотичного чинника на
ляції Вивірки звичайної. Про який чинник ідеться?
А вирубування дерев у лісі
Б зменшення кількості опадів
В збільшення популяції куниці
Г пониження температури повітря
3. Укажіть сукупність організмів, які пов’язані між собою трофічними зв’язками.
А вид
Б зграя
В популяція
Г ланцюг живлення
4. До трофічної групи продуцентів належить
А ялина зелена Б коник зелений
В жаба зелена
Г чапля біла
5. Унаслідок якого процесу кисень повертається в атмосферу?
А транспірації
Б гліколізу
В хемосинтезу
Г фотосинтезу
6. Укажіть організми, які забезпечують
А азотобактерії
Б нітрифікувальні бактерії
В денітрифікувальні бактерії
Г бактерії гниття
7. Укажіть правильну
відображають
ІІ. Максимальне збільшення чисельності
не збільшення чисельності
Чи є поміж них правильні?
А правильне лише І
Б правильне лише ІІ
В обидва правильні
Г немає правильних Тестове завдання з
10.Ознайомтеся зі схемою трофічної сітки (стрілки напрямлені в бік споживача). Схарактеризуйте її за наведеними ознаками.
Літерою
1
На третьому трофічному рівні перебувають об’єкти, позначені літерою
1 лише А
2 лише Г 3 лише Б, В
Літерою Г позначено
1 рослину 2 рослиноїдну тварину 3 хижака
що
виваженого) розвитку.
конференції створено Стокгольмську декларацію, яка
слідками, що призводило до виникнення протиріччя між людським суспільством і навколишнім середовищем. Різким ростом антропогенного впливу на навколишнє середовище зумовлено ускладнення взаємовідносин суспільства і природи на порозі ХХІ століття. Поняття екологічної проблеми. Людство стикається з необхідністю розв’язання багатьох проблем, які виникають у результаті різкого погіршення якості навколишнього середовища. ! Екологічна проблема – це зміна природного середовища в результаті антропогенних впливів, що спричинює порушення структури і функціонування природних систем і призводить до негативних соціальних,
вого співтовариства.
• атмосферні (забруднення атмосфери: радіологічне, хімічне, механічне, теплове);
• водні (виснаження й забруднення поверхневих і підземних вод, забруднення морів і океанів);
• геолого-геоморфологічні (порушення рельєфу й геологічної будови);
• ґрунтові (забруднення ґрунтів, ерозія, заболочування);
• біотичні (знищення лісів, зменшення видового різноманіття);
• комплексні (ландшафтні) – спустелювання, зниження біорізноманіття, порушення режиму природоохоронних територій. Протягом останніх 50 років відбувається інтенсивне зростання чисельності населення планети та бурхливий науково-технічний прогрес, що спричинює погіршення стану багатьох екосистем планети, зменшення їхньої біопродуктивності й біорізноманітності. Сучасні екологічні проблеми у світі. Однією з екологічних проблем є зростання кількості міст-гігантів, що стали найбільшими забруднювачами довкілля. Населення світу проживає в поселеннях двох типів: міських і сільських. Міським є поселення, де більша частина людей працює в промисловості та сфері послуг. У сільському поселенні більшість жителів зайнята в аграрному секторі господарства.
міського способу життя. Нині в міських поселеннях проживає
ловина
сучасних промислових технологій може стати вичерпання запасів
зелені рослини не встигатимуть його відтворювати. У деяких посушливих районах земної кулі екологічною проблемою є й спустелювання.
Вивчення динаміки споживання людством мінеральних ресурсів показало, що можуть, у майбутньому, вичерпатися запаси нафти, вугілля, горючих сланців і торфу (рис. 169).
Важливою екологічною проблемою є й забруднення атмосфери різними хімічними викидами промислового характеру, що призводить до збільшення площ озонових «дір» і розвитку парникового ефекту. Поява так званих озонових «дір» спричинила зниження захисної дії озонового шару від сонячного ультрафіолетового випромінювання. А парниковий ефект приводить до потепління клімату, танення льодовиків, підвищення рівня Світового океану і зрештою затоплення й руйнації екосистем окремих районів суходолу. Глобальною екологічною
різноманіття водних
річок отруйними стоками тощо. Україна посідає
й аварія на Чорнобильській АЕС, яка має досі
подолані наслідки в нашій країні. Україна має найвищий інтегральний показник антропотехногенних навантажень на природне середовище практично на всій території, порівняно з іншими країнами Європи. На стан екологічної ситуації в регіонах України впливає також вияв еколого-географічних проблем. Поміж них для України характерними є: зменшення запасів корисних копалин, вичерпання ресурсів, зміна структури земельних ландшафтів, зниження родючості ґрунтів, скорочення розмаїття рослинного й тваринного світу. Ці проблеми зумовлені кількома причинами: структура господарства в багатьох регіонах не відповідала їхньому інтегральному потенціалу, не враховувались об’єктивні потреби й інтереси
логічні можливості конкретної території тощо (рис. 170). Отже, екологічні
Проаналізуйте карту. Прочитайте твердження. І. Райони з напруженими умовами проживання збігаються з найбільш розвинутими промисловими районами України.
ІІ. Райони зі сприятливими умовами проживання збігаються з аграрними районами України Чи є поміж тверджень правильні?
1.
2.
3.
Забруднення
Поміж глобальних цілей сталого розвитку є боротьба зі зміною клімату, збереження морських екосистем та екосистем суходолу.
Які причини виникнення цих проблем?
Однією з причин виникнення екологічних проблем є
на стан навколишнього середовища чинників, які змінюють його кількісні та якісні характеристики.
Поняття забруднення довкілля та його види. Ці чинники можуть бути фізичного, хімічного або
нення довкілля.
родних процесів
бруднення є результатом
(токсичні сполуки – ртуть, свинець). Нестійкі забруднювачі негативно діють короткий період, знешкоджуються в екосистемах унаслідок
них фізико-хімічних чи біологічних процесів. Якщо в 40-х роках XX ст. ще домінували натуральні продукти (бавовна, шовк, вовна, мило, практично без добавок), то в наш час у промислово розвинутих країнах вони замінені синтетичними, що важко розкладаються й забруднюють навколишнє середовище (синтетичне волокно, мийні засоби, мінеральні добрива тощо).
Відповідно до природи чинників, забруднення розділяють на чотири групи: механічне, фізичне, хімічне та біологічне.
Механічне забруднення пов’язане з надходженням у навколишнє середовище агентів, які чинять лише механічний вплив без фізико-хімічних наслідків. Джерелами забруднення може бути виверження вулканів, пожежі, очисні споруди міст, полігони твердих побутових відходів (рис. 172).
Фізичне забруднення пов’язане зі змінами температурних, електромагнітних, шумових, світлових і радіаційних параметрів зовнішнього середовища. Джерелами теплового забруднення є промислові викиди нагрітого повітря, димових газів і води. Електромагнітне забруднення
Сміття побутове,
відходи побутові, органічний і
неорганічний
пил, сажа, смолянисті речовини
Теплове, шумове, електромагнітне, світлове, радіаційне випромінювання
Хімічні речовини:
оксиди, кислоти, солі важких металів, пестициди, нітрати, пластмаси, синтетичні поверхневоактивні речовини (СПАР)
Біотичне, мікробіологічне, продукти генетичної інженерії
небезпечними щодо фізичного забруднення є атомні електростанції – основне джерело радіоактивного забруднення. Хімічне забруднення – збільшення кількості хімічних компонентів певного середовища, а також проникнення (введення) в нього хімічних речовин, не притаманних йому, або в концентраціях, котрі перевищують норму. Негативний вплив хімічних забруднювачів на здоров’я людини суттєвий: вони порушують нормальне функціонування організму, багато хімічних речовин мають канцерогенні та мутагенні властивості (рис. 173). Біологічне забруднення – випадкове або пов’язане з діяльністю людини проникнення в екосистеми не притаманних їм рослин, тварин і мікроорганізмів (бактеріологічне й вірусологічне). Особливо забруднюють середовище підприємства, які виробляють антибіотики, ферменти, вакцини, сироватки, кормовий білок, тобто підприємства промислового біосинтезу, у викидах якого наявні живі клітини мікроорганізмів. До біологічного забруднення можна віднести надмірну експансію організмів (наприклад, у містах несвоєчасне прибирання побутових відходів призводить до значного збільшення кількості щурів, комах, голубів). Якість довкілля та критерії забруднення. Забруднення, особливо антропогенного походження, спричиняє гостру екологічну кризу, зумовлену деградацією об’єктів навколишнього середовища.
Карбон(ІІ)
оксид (чадний газ)
Вуглеводні (бензин, метан)
крові утворює карбоксигемоглобін, що може призвести до погіршення гостроти зору, роботи серця та легенів, порушення дихання і навіть смерті
Мають наркотичну дію, викликають головний біль, запаморочення
Плюмбум Викликає головний біль, анемію, нервові розлади, пологові дефекти, затримку фізичного та психічного розвитку
Пестициди Мають канцерогенний вплив, спричинюють ушкодження печінки, порушення ембріонального розвитку Нітрати Викликають утруднення дихання, підвищують дитячу смертність, унаслідок хімічних перетворень утворюються канцерогенні сполуки Радіонукліди Мають канцерогенний вплив, призводять до мутацій
ті середовища до самовідновлення. Природно-соціальний підхід
оцінювання стабільності середовища існування людини. Він вимагає
блення й дотримання певних нормативних законодавчих документів
рони природи – стандартів якості довкілля, якими встановлено оптимальні показники природного середовища – критерії. Критерії кількісного оцінювання рівня забруднення навколишнього середовища – це індекс забруднення, гранично допустима, фонова і токсична концентрації. Індекс забруднення (ІЗ) – показник, що якісно і кількісно відображає наявність у довкіллі речовини-забруднювача і ступінь її
ми. Гранично допустима концентрація (ГДК)
шкідливої речовини в навколишньому середовищі, яка під час постійного контакту або
ний проміжок часу практично
цію встановлююють у приземній атмосфері,
Дайте
Одна
проживе й кількох хвилин.
води – тиждень,
Види забруднення атмосфери. Забруднення атмосферного повітря за джерелом проходження бувають природними (викликані природними процесами) та антропічними (викликані викидом різних забруднювальних речовин у результаті діяльності людини) (рис. 175). За площею поширення розрізняють три типи атмосферного забруднення. Перший – місцевий, для якого характерний великий уміст речовин на малих територіях (район, місто). Другий – регіональний, за якого забруднення поширюється на значний простір. Третій – глобальний, за якого відбувається поступове накопичення екологічних і кліматичних змін планетарного масштабу. Забруднення викликають забруднювачі, які розрізняють за агрегатним станом: тверді (пил, сажа, смолисті речовини тощо), рідкі (кислоти, луги, солі) та газуваті (оксиди Карбону, Нітрогену, Сульфуру та вуглеводні). Саме газуваті забруднювачі становлять 90 % загальної маси речовин, що надходять в атмосферу. ! Забруднення атмосфери – надходження
і значним є хімічне забруднення середовища не властивими йому речовинами: карбон(ІІ) оксидом (чадним газом), сульфур(ІV) оксидом, оксидами Нітрогену, сполуками Хлору, Флуору, Плюмбуму, вуглеводнями. Наслідки забруднення атмосферного повітря. Головними екологічними глобальними наслідками антропічного забруднення атмосфери є парниковий ефект, руйнування озонового шару, кислотні дощі і смог.
Частина енергії сонячних променів, відбиваючись від поверхні землі, затримується молекулами різних газів (вуглекислий газ, метан), що зумовлює нагрівання поверхні Землі. Господарська діяльність людини збільшує частку цих газів в атмосфері. Унаслідок цього порушується тепловий баланс, що виявляється в підвищенні температури поверхні Землі та приземного шару повітря. Таке явище називають парниковим ефектом. Небезпека збільшення парникового ефекту полягає в зміні таких кліматичних параметрів, як кількість опадів, океанічні течії, розміри полярних крижових шапок. Це може призвести до глобального потепління, яке спричинить танення льодовиків.
зміщення кліматичних зон у
Землі. Саме в цьому шарі інтенсивно поглинається короткохвильова
олетова частина сонячної радіації, тим самим перешкоджаючи потраплянню її на поверхню планети. Зменшення вмісту озону спричинене руйнуванням молекул озону внаслідок хімічних реакцій з атомами Хлору й Брому, що вивільняються під час фотохімічного розпаду молекул фреонів (хладагенти в холодильниках, аерозолі), а також з оксидами Нітрогену (продуктами спалювання ракетного палива). Зменшення вмісту озону в атмосфері призводить до збільшення ультрафіолетового фону, що загрожує пригніченням росту рослин, зниженням урожайності сільськогосподарських культур, розвитком захворювань тварин і людей, збільшенням кількості мутацій тощо.
Краплини сульфатної та нітратної кислот утворюються в результаті сполучення з атмосферною вологою оксидів Сульфуру та Нітрогену, що викидаються в атмосферу внаслідок роботи теплових електростанцій (ТЕС) та автомобільних двигунів. Ці кислоти
туману й
дають на землю кислотними дощами – атмосферними опадами, кислотність яких вища від нормальної.
врожайності сільськогосподарських культур і
(вимиваються Кальцій, Калій і Магній), порушуються
нювальних речовин вона не встигає самоочищуватися. Тож необхідно зменшити антропічне навантаження на атмосферу. Основним і найефективнішим методом боротьби із забрудненням атмосфери є економічний (система заохочувальних і заборонних заходів). Технологічні методи боротьби – технологічне переобладнання підприємств, що забруднюють атмосферу. Якість повітря в нашій країні регулює Закон України «Про охорону атмосферного повітря» (1992). Він спрямований на збереження та відновлення природного стану атмосферного повітря, створення сприятливих умов для життєдіяльності, забезпечення екологічної безпеки та запобігання шкідливому впливу атмосферного повітря на здоров’я людей і навколишнє природне середовище.
Головними заходами в галузі охорони атмосферного повітря
конструкції промислових
редовища в житлових і громадських
Рис. 178. Різновиди смогу
Фотохімічний (сухий – Лос-Анджелеського типу)
Умови утворення: висока забрудненість атмосфери, сонячна погода, низька вологість повітря, температура повітря +30 °С, відсутність вітру.
якістю повітря.
Димовий (вологий – Лондонського типу)
Умови утворення: висока концентрація продуктів спалювання твердого і рідкого палива (SO2, СО, сажа),
Антропічний
Дайте означення поняття гідросфера.
Яка роль води в організмі, в екосистемах?
Вода є важливим елементом біосфери і як екологічний чинник, і як середовище існування. Вона займає понад 70 % площі Землі, й це переважно солона морська вода, натомість запаси прісної води становлять лише 2 % загальної її кількості. Прісна вода зосереджена переважно в льодовиках (85 % від загальної кількості), і лише 1 % прісної води містять річки, озера й підземні води. Антропічний вплив на гідросферу. У сучасних умовах постійно збільшується потреба у воді. Водночас відбувається погіршення якості води й водних джерел та зменшення можливостей їх використання. Особливо гострою є проблема забезпечення людства достатньою кількістю прісної води. Однією з причин такої ситуації є забруднення водойм. ! Забруднення водойм – надходження у водойми різних забруднювачів у кількостях і концентраціях, здатних порушити нормальні умови середовища. Розрізняють забруднення хімічне, фізичне, теплове й біологічне (рис. 179). Хімічне забруднення виникає внаслідок надходження у водойми шкідливих домішок зі стічними водами. Домішки бувають неорганічної (кислоти, мінеральні солі, луги тощо) й органічної природи (нафта й нафтопродукти, органічні сполуки, поверхнево активні речовини, мийні засоби, пестициди тощо). Поміж них найпоширеніші сполуки Арсену, Плюмбуму, Меркурію, Купруму, Хрому, Флуору тощо. Вони є отруйними для мешканців водойм,
Рис. 179 . Види забруднення водойм
суспензії, осідаючи на дно водойм, припиняють життєдіяльність мікроорганізмів, що беруть участь у самоочищенні екосистем. Фізичне забруднення відбувається внаслідок потрапляння у воду різних механічних домішок (піску, шлаків тощо). Причиною радіоактивного забруднення є ядерні випробування, аварії на атомних підприємствах і накопичення радіоактивних відходів.
Теплове забруднення пов’язане з підвищенням температури води в результаті її змішування з теплими технологічними водами підприємств.
Біологічне забруднення характеризується появою у воді патогенних бактерій, вірусів, найпростіших, грибів тощо. Джерелом такого забруднення можуть бути стоки комунально-побутових підприємств, дослідницьких лабораторій тощо.
Джерела забруднення гідросфери. Основними джерелами потоків стічних вод є промислові підприємства.
господарства є джерелами забруднення пестицидами, сполуками
талів, нітратами і нітритами тощо (рис.
Рис.
водойми як екосистеми. Можна вирізнити такі принципи оцінювання екологічного стану водойм: • комплексне вивчення чинників існування водойми, зокрема гідрологічних і гідрохімічних показників басейну водної системи, природно-кліматичних особливостей, продуктів взаємодії забруднювальних речовин у різних хімічних і біохімічних реакціях, які відбуваються у водному середовищі, тощо;
• реалізація екосистемного підходу з урахуванням трофічних рівнів екосистеми;
• урахування двох критеріїв оцінювання стану водойми: гранично допустимих концентрацій (ГДК) і впливу на гомеостаз водної екосистеми.
Тому значні перспективи в застосуванні мають біологічні методи моніторингу стану гідросфери, які ґрунтуються на використанні біологічних об’єктів та оцінюванні реакції організмів або клітин на вплив забруднювальних чинників водного середовища. Ступінь забруднення водних
присутністю (або відсутністю) організмів-індикаторів, виходячи з порівняння видового різноманіття, чисельності та біомаси населення забруднених і чистих зон. У разі такого порівняння користуються абсолютними величинами й індексами видового різноманіття. До основних напрямів біологічного моніторингу належать біоіндикація (спосіб
що полягає в зміні забарвлення води внаслідок масового розмноження ціанобактерій. Вони здатні виробляти отруйні речовини у великих концентраціях. Цвітіння викликає зміну кольору води й погіршує кисневу забезпеченість вод. Підсилюють прояв цього явища забруднення водойм
здійснюють моніторинг (рис. 182). Охорона природних вод потребує зусиль усієї людської спільноти, які регулюються на законодавчому рівні. Основним документом, яким регулюються відносини з використання й охорони природних вод, є Водний Кодекс (ухвалений Верховною Радою України 1995 року). Відповідно до Водного Кодексу та для його реалізації розробляють підзаконні акти. Зокрема, в Україні відповідно до «Основних напрямків державної політики України в галузі
ни довкілля, використання природних ресурсів
екологічної безпеки» до пріоритетних напрямків належить поліпшення
стану басейну Дніпра та якості питної води, запобігання забрудненню Чорного й Азовського морів. Стратегічні
морського довкілля відображені в Конвенції про захист
нень. Конвенція підписана Україною 1992 року й ратифікована 1994 року. Поміж позитивних чинників, що сприяють оздоровленню морського довкілля, є прибережні об’єкти природно-заповідного фонду. Лише
багаторічної діяльності різних організмів, води, повітря, сонячного тепла й світла (рис. 183).
Однією з характеристик ґрунтів є родючість – сукупність властивостей ґрунту (уміст гумусу, доступних для рослин поживних речовин, кисню, вологи тощо), які забезпечують урожай сільськогосподарських рослин, тому в багатьох країнах саме земля є основним національним багатством. Зокрема, в Україні нараховують понад 38 типів ґрунтів, тож це одна з найбільших країн Європи з могутнім земельно-ресурсним
різко посилюється внаслідок
земель. Порушення механічної структури ґрунтів
виникати
заболочування – підвищення вологості ґрунту, що спричинюється підняттям рівня ґрунтових вод. До такого процесу може призвести будівництво ставків, водосховищ, земляних валів, водовідвідних дамб тощо.
Джерела забруднення ґрунтів. Одним з наслідків посилення виробничої діяльності людини є інтенсивне забруднення ґрунтового покриву. Найпоширенішими забруднювачами ґрунтів антропічного походження є побутові відходи, мінеральні добрива, важкі метали, радіонукліди, пестициди, нафтопродукти. Значні обсяги побутових відходів (харчові, фекалії, сміття – побутове, будівельне, громадських закладів) забруднюють ґрунти і роблять їх не придатними для використання в сільськогосподарському виробництві (рис. 185). Джерелом забруднення є автомобільний транспорт
що пальне (бензин) містить важкий
вості. Видалення рідких і твердих
або науково-дослідних установ,
атомної енергії, є причиною радіаційного
На хімічний склад ґрунтів упливає сучасне сільське господарство, що широко використовує добрива і різноманітні хімічні речовини для боротьби зі шкідниками, бур’янами і хворобами рослин – пестициди. З кожним роком виробництво та застосування добрив і отрутохімікатів у сільському господарстві зростає. Недоречне й безконтрольне використання їх призводить до порушення кругообігу речовин у біосфері. Пестициди згубно діють на ґрунтову мікрофлору. До тяжких екологічних наслідків призводять техногенні аварії, якщо вони пов’язані з використанням, виробництвом чи транспортуванням токсичних хімічних речовин. Високі концентрації речовин-забруднювачів, що потрапляють у довкілля, можуть спричиняти загибель усього живого в місці аварії. Глобальними за наслідками були аварії на АЕС «Фукусіма-1», ЧАЕС (рис. 186). Унаслідок аварії на ЧАЕС у навколишнє середовище викинуто небезпечні радіонукліди: Стронцій, Цезій, Плутоній, Йод. Радіоактивного забруднення у зв’язку з аварією і подальшим поширенням радіонуклідів


повань
сформованих людиною, які замінили природні. Для досягнення найвищого господарського ефекту в кожній екосистемі
своє науково обґрунтоване співвідношення між полем, лісом, луками, болотами. Важливими заходами є створення, реставрація й підтримування полезахисних лісових смуг для закріплення межі полів і захисту від ерозії (рис. 187). З метою збереження ґрунтів упроваджують органічне землеробство. Це передбачає відмову від застосування отрутохімікатів
торфу, компостів тощо). Для розв’язання проблеми побутових відходів
перероблення природних ресурсів з використанням безвідходних технологій, що повністю виключали б утворення та накопичення відходів господарської діяльності (рис. 188). Правові основи охорони, відтворення та підвищення родючості ґрунтів, збереження екологічних функцій ґрунтового покриву та охорони довкілля в нашій країні визначає
(2003). Людство, на жаль, продовжує і
довкілля й розвитку (Ріо-де-Жанейро, 1992) є Конвенція про біорізноманіття. У ній уперше проголосили необхідність збереження біорізноманіття спільним завданням і пріоритетним напрямом діяльності
збереження біосфери. ! Біорізноманіття – сукупність різноманітних об’єктів
будь-якої
критерію. Розрізняють біорізноманіття видове (сукупність усіх видів організмів, що населяють нашу планету, тобто загальний генофонд Землі), генетичне (сукупність генофондів різних популяцій
(сукупність екосистем планети). Причини зменшення біорізноманіття. Біорізноманіття
го середовища. Але з появою людини
єю, вплив на біорізноманіття став
5 759 32115,619,664,9
53 311 55743,527,029,5
33 985 31648,935,815,4 Пн. Америка 26 179 90756,318,824,9 Пд. Америка 20 120 34662,522,515,1 Австралія 9 487 26262,325,812,0 Антарктида 13 208 983100,00,00,0
Одним зі шляхів відновлення або збільшення біорізноманіття є акліматизація – пристосування організмів до
вих умов мешкання, у які вони потрапили природним шляхом
чи випадково перенесені
Такими, що акліматизувалися, уважають організми, які в нових умовах нормально розвиваються й дають життєздатне потомство (рис. 190). З метою відновлення на певній території видів місцевих організмів, що зникають або вже зникли, проводять реакліматизацію. Таким шляхом у заповідниках України була відновлена популяція Зубра європейського. Законом України «Про тваринний світ» (2001 р.) заборонене самовільне переселення тварин на незвичні місця проживання й акліматизацію нових тварин. Варто пам’ятати, що дослідження організмів дає поштовх до розвитку багатьох напрямів науки. Наприклад, відкриття, яке лежить в основі важливих для медицини методів, може відбутися в
абсолютно не пов’язаній з людиною. Зокрема, розробка полімеразної ланцюгової реакції
вою без відкриття ДНК-полімерази, яка
болотяна
з акліматизації рослин проводять ботанічні сади й дендропарки, а тварин – деякі заповідники й зоопарки. За акліматизації важливими чинниками є кліматичні умови, наявність кормової бази, відсутність потенційних природних ворогів. Стенобіонтним видам важко адаптуватися до умов життя в іншому регіоні або на іншому континенті.
природи?
Як здійснюють охорону біорізноманіття?
З метою визначення порядку й умов охорони природи, прав та обов’язків природокористувачів, їхньої відповідальності
природи
навколишнього природного середовища» (1991 р.). Також до важливих
жать кодекси України: земельний, водний, лісовий, про надра. Створені закони «Про природно-заповідний фонд України», «Про використання ядерної енергії та радіаційну безпеку», «Про охорону атмосферного повітря» тощо. На підставі цих документів відповідні
і науково обґрунтованого, невиснажливого використання рослинного й тваринного світу. Зокрема,
ня тварин у мисливстві, рибальстві, висуває вимоги до користувачів тваринним світом, створює підґрунтя для роботи природоохоронних установ (рис. 191). Відносини в галузі лісокористування
випасання худоби, збирання ягід і
культурно-оздоровчих, рекреаційних
декс.
Рис. 191. Зоопарк – природоохоронна, науково-дослідницька та культурно-освітня установа
Стаття 45. Розведення в неволі рідкісних та таких, що перебувають під загрозою зникнення, видів тварин. «Розведення в неволі рідкісних та таких, що перебувають під загрозою зникнення, видів тварин може дозволятися з метою їх збереження, охорони і відтворення насамперед, якщо цього неможливо досягнути в природних умовах, а також у науководослідних
ми. Перший напрям
що охороняють природу як єдине ціле, третій – закони, що регулюють використання природних ресурсів на території держави. Міжнародні угоди в галузі природокористування й охорони навколишнього природного середовища, у яких бере участь Україна, є для нашої країни джерелами національного екологічного права. Прикладом міжнародно-правового акту як джерела екологічного права є Декларація Ріо з навколишнього середовища і розвитку. Вона була ухвалена на Конференції ООН 1992 року в Ріо-де-Жанейро (Бразилія). У ній сформульовані найважливіші 27 принципів екологічної поведінки держав, якими вони мають керуватися. В екологічному законодавстві України частка міжнародно-правових угод є досить
кожним роком зростає. Збереження видового різноманіття. Для збереження видового різноманіття вчені Міжнародного союзу
розкритий, Тюльпан двоквітковий, Лілія лісова тощо (рис. 192).
542 види рідкісних тварин, поміж яких Мідянка звичайна, Лелека чорний, Ведмідь бурий, Кіт лісовий, Кінь дикий, Заєць білий тощо (рис. 193). В Україні вперше у світі розробили Зелену книгу, до якої заносять рідкісні й типові для певної місцевості рослинні угруповання, що потребують установлення особливого режиму їх використання. На жаль, існує й «чорний список» – міжнародний перелік видів рослин і тварин, які зникли, починаючи з 1600 р. Підставою для внесення певного виду до цього списку є відсутність достовірних відомостей про його існування принаймні впродовж останніх 50 років. За даними МСОП на 2008 рік, за останні 500 років повністю вимерли 844 види тварин і рослин, поміж яких Дронт маврикійський, Орел Хааста, Моа тощо (рис. 194). Види організмів охороняють і відновлюють на різноманітних природоохоронних територіях. В Україні створено національні біосферні та природні заповідники, природні парки, заказники, пам’ятки природи, а також регіональні ландшафтні парки, заповідні урочища, ботанічні сади, зоологічні парки, дендрологічні парки та парки-пам’ятки садово-паркового мистецтва. Загальна площа природно-заповідного фонду України становить 2,8 млн га. В Україні засновано

Дронт маврикійський (Додо) – не-
літаючий птах, що
був поширений на
острові Маврикій.
Мав близько метра в довжину й важив близько 20 кг. Уперше описаний голландською експедицією (1598 р.). До середини XVII
у
состеповій зоні – «Медобори» (рис. 196), у степовій – Український степовий. Природні парки – природоохоронні, науково-дослідні та культурнопросвітницькі установи. До них належить, наприклад, парк «Подільські Товтри». З метою збереження й відтворення певних природних комплексів або окремих видів організмів створюють заказники.
Окремі унікальні природні утворення, що мають природоохоронне, наукове, естетичне або пізнавальне значення, називають пам’ятками природи. Прикладом є унікальне озеро Синевир. Ботанічні сади створюють з метою вивчення, збереження, акліматизації рідкісних видів місцевої та світової флори, а також для проведення освітньо-виховної роботи. Національний ботанічний сад імені Миколи Гришка
садів Європи (рис. 197). В Україні працюють 13 зоологічних
Поясніть поняття сталий розвиток.
Нерозв’язаність екологічних проблем поставила людство на межу біосферної кризи, яка загрожує самому його існуванню. Наразі
закони природи, або ж усвідомити відповідальність перед
Стратегія сталого розвитку природи і суспільства. Сучасне покоління стає безпосереднім учасником формування нового екологічного світогляду. Створення економічних і політичних умов для екологічно стабільного розвитку можливе лише на основі переорієнтації людської свідомості. Вочевидь, із глобальними проблемами неможливо впоратися, діючи роз’єднано, тому особливого значення набуває природоохоронна робота міжнародних організацій (рис. 198). У 1987 р. Міжнародна комісія ООН з навколишнього середовища і розвитку під головуванням експрем’єра Норвегії Ґру Гарлем Брундланд
звіт
спільне майбутнє», у якому поняття сталого розвитку визначено
якими користуємося ми.
ЮНСЕД – Конференція ООН з навколишнього середовища й розвитку (United Nations Conference on Environment and Development)
Комісія ООН зі сталого розвитку (United Nations Commission on Sustainable Development).
ВООЗ – Всесвітня організація ООН з питань охорони здоров'я (World Health Organisation).
МСОП – Міжнародний союз охорони природи (International Union for Nature Conservation).
Примітка. Перелік організації
цес адаптації ЦСР до вітчизняного законодавства. Беручи
«нікого не залишити осторонь» і використовуючи широкий
маційних, статистичних та аналітичних матеріалів, було розроблено національну систему ЦСР. У 2017 році Уряд України представив Національну доповідь «Цілі сталого розвитку: Україна», у якій подано результати адаптації 17 глобальних
тку, а саме 86 конкретних завдань і 172 показники для моніторингу
рішеннях. У цей же час вкрай загострилися екологічні проблеми, які з локальних перетворилися на національні та глобальні загрози. Дослідженням цих проблем, поряд з іншими, займається галузь знання, яка має велике прикладне значення, – природокористування. Природокористування як наука сформувалося відносно недавно (друга половина – остання третина ХХ століття), коли стало досить очевидним, що природні блага вичерпні, повинні мати економічну оцінку і не можуть розглядатися як безкоштовний дар природи. У ній широко використовуються дані природничих наук: біології, екології, географії тощо.
! Природокористування – наука про можливості та напрями екологічно безпечного та невиснажливого використання ресурсів і властивостей
для забезпечення сталого розвитку.
За сталого розвитку при плануванні
враховувати такі положення:
• темпи споживання природно-ресурсного потенціалу
більшувати природних умов регенерації екосистеми;
• об’єми відходів виробничо-господарської та соціокультурної діяльності не повинні перебільшувати асиміляційні властивості
Рис.
збереження природного середовища життєдіяльності людського суспільства. Поняття про екологічне мислення. Для вирішення
екологічна свідомість, яка зумовлює здатність усвідомлювати сучасний екологічний стан і прогнозувати наслідки діяльності людства. Формування екологічної свідомості
гічної інформації, яка може забезпечувати різний ступінь екологічних знань, різну їх глибину залежно від індивідуальних
і професійної належності. На базі екологічної свідомості формується екологічне мислення. ! Екологічне
передбачає усвідомлення особистістю об’єктивної реальності навколишнього світу, своїх дій і способу життя з метою зведення до мінімуму або уникнення екологічних проблем. Однією з характеристик екологічного мислення
ної небезпеки. Також важливим є
Рис.
1.
2.
5.
Практична робота.
Оцінка екологічного стану свого
Мета: з’ясувати екологічний стан свого регіону
1. Ознайомтеся з інформацією. «Рівень забруднення навколишнього середовища залежить
багатьох факторів. Це кількість автотранспорту й інтенсивність його руху, кількість підприємств, що розташовані на
ників
го спостереження,
Забруднення атмосферного
Зміна кліматуТемперату
Земельні ресурси та ґрунти
4.
охороняю ться
Тенденції змі ни чисельно
Вилучення земель
субстрати, такі як рідкий
визначають економічні
переваги (тис. грн/га) виробництва біометану (рис.)».
Завдання
А біоніки
Б біофізики
В біотехнології
Г біоінформатики Завдання 2. Організми, унаслідок
екосистемах належать
А продуцентів Б редуцентів
В консументів Завдання 3.
Самоконтроль рівня навчальних досягнень. СТАЛИЙ
ПРИРОДОКОРИСТУВАННЯ
Тестові завдання з однією правильною відповіддю (0,5 бала)
1. Глобальною сучасною екологічною проблемою можна вважати, зважаючи
масштаби впливу
А зменшення потужності озонового шару
Б електромагнітне випромінювання
В шумове забруднення
Г забруднення ставка
2. Антропічне забруднення може бути спричинене
А виверженням вулкану
Б вивітрюванням гірських порід
В масовим розмноженням комах
Г внесенням у ґрунт добрив
3. Чинником фізичного забруднення є
А побутове сміття
Б солі важких металів
В світлове випромінювання
Г продукти генетичної інженерії
4. Який чинник спричинює заболочення ґрунтів?
А будівництво ставків і водосховищ
Б незбалансоване зрошення
В випадіння кислотних дощів
Г радіаційне опромінення
5. Акліматизація – це
А зміна клімату внаслідок руйнації озонового шару
Б сукупність методів вивчення кліматичних показників
В пристосування організмів до нових умов мешкання
Г відновлення на певній території
8.
Г немає правильних
9. Учень та учениця аналізували діаграму перевищення гранично допустимих концентрацій (ГДК) забрудників повітря. Учень зазначив, що лише
нітроген(IV) оксид перевищує гранично допустимі концентрації в повітрі. Учениця зауважила, що карбон(ІІ) оксид оксид та феноли містяться в
повітрі в ГДК.Чи має хтось рацію?
А лише учень
Б лише учениця
В обидва мають рацію
2 збільшення кількості мутацій
3 прискорення росту рослин
1 Карпатський
наукової основи.
цилінів методами ферментації, почалась ера антибіотиків, спричинивши розвиток мікробіологічного синтезу та створення мікробіологічної промисловості. У 60–70-ті роки ХХ ст. розпочався бурхливий розвиток клітинної інженерії. Лауреатами Нобелівської премії 2012 року
став британський учений Джон Гердон та японський дослідник Сін’я
року Дж. Гердон провів експеримент, що
клонування. Через понад
плюрипотентні стовбурові клітини, які можуть розвиватися в
типу.
розробки способів
Що таке вид, популяція?
Що таке генотип, фенотип, спадкова мінливість, природний добір?
У попередніх класах ви вже ознайомилися із закономірностями успадкування ознак та еволюційних змін, що відбуваються
підґрунтям для опанування знань про селекцію організмів.
Рис.
Важливою умовою ефективності штучного добору є різноманіття вихідного матеріалу. Для цього використовують плідників з різних географічних областей. Існує масова й індивідуальна форми штучного добору. Масовий добір, за якого добирають особин з особливостями фенотипу, простий у застосуванні. Але особини, подібні за фенотипом, можуть виявитися різнорідними за генотипом, тож ефективність добору буде незначною. За індивідуального добору плідників добирають за результатами вивчення як фенотипу, так і генотипу. Метод, який уможливлює різноманітність селекційного матеріалу, – гібридизація. ! Гібридизація – процес отримання гібридів, в основі
застосовують міжвидову
(рис. 203).
нення.
Неспоріднене схрещування (аутбридинг) – це гібридизація між організмами різних ліній. У гібридів шкідливі алелі переходять у гетерозиготний стан – спостерігається явище гетерозису. ! Гетерозис (гібридна сила) – явище, за якого перше покоління гібридів, отриманих у результаті неспорідненого схрещування, має підвищені життєздатність, продуктивність, ріст і стійкість проти захворювань. Гетерозис у природі властивий багатьом групам організмів (рис. 204). Він виник водночас зі статевим розмноженням і може бути зумовлений генетичними причинами: у гетерозигот гаситься шкідлива дія рецесивних алелей; спостерігається дія сприятливих домінантних алелей, які наявні в батьківських формах і поєднуються в нащадків; спостерігається більш повне вираження деяких генів у гетерозигот, ніж у гомозигот. Особливості селекції рослин. Рослини як об’єкти селекції мають низку особливостей. Вони вирізняються високою плідністю, тому селекціонери часто застосовують масовий добір. Для рослин характерне
множення, завдяки якому
чимало українських сторінок. В Україні, на Миронівській селекційній станції, було створено багато сортів рослин, зокрема високоврожайні сорти озимої
тю в екстремальних умовах (рис. 205). Особливості селекції тварин. Для багатьох тварин характерні невелика кількість потомства та значна тривалість життя. Тому в тваринництві зазвичай застосовують індивідуальний добір. Свійські тварини – роздільностатеві організми, для них характерне лише статеве розмноження. У селекції тварин застосовують споріднене та неспоріднене схрещування (часто виявляється явище гетерозису), а також віддалену гібридизацію для виведення нових порід. Крім того, користуються методом визначення якостей плідників за показниками потомства.
Особливості селекції мікроорганізмів. Прокаріотів та одноклітинних еукаріотів використовують у харчовій, кормовій, виноробній промисловостях, а також для біологічної боротьби зі шкідниками. Гібридизація для мікроорганізмів майже
У селекції мікроорганізмів, як і в рослин, широко
(1907 – 1983)
1.
Видатним українським селекціонером є
Він був директором Миронівського інституту селекції і насінництва пшениці. Шедевром світової селекції вважають сорт «Миронівська–808», а загалом В. Ремесло створив і районував 20 сортів озимої пшениці. Наразі провідними установами України в галузі селекції є Інститут фізіології рослин та генетики (м. Київ) та Інститут рослинництва ім. В. Я. Юр’єва (м. Харків). За останні 30 років у світі та в Україні створено високогетерозисні гібриди жита озимого. В Україні за останні роки створено 32 сорти ячменю ярого.
Що таке селекція?
Що таке вид, рід, сорт, порода, штам?
Вивченням спадкової мінливості культурних рослин і їхніх предків займався відомий генетик та селекціонер Микола Вавилов (1887–1943). Багаторічні дослідження дозволили йому 1920 року сформулювати закон гомологічних рядів спадкової мінливості. Закон гомологічних рядів спадкової мінливості. Сутність закону полягає в тому, що генетично близькі види й роди характеризуються схожими рядами спадкової мінливості з такою правильністю, що, знаючи ряд форм у межах одного виду, можна передбачати знаходження паралельних форм у інших близьких видів і родів. Що ближче генетично розташовані в загальній системі види й роди, то повніша схожість у рядах їхньої мінливості. На прикладі злакових М. Вавилов показав, що схожі мутації виявляються в цілій низці представників цієї родини. У м’якої та твердої пшениці, а також ячменю відомі форми з довгими та короткими
Гомологічні ряди спадкової мінливості за остюками:
1-4 – м’яка пшениця; 5-8 – тверда пшениця; 9-12 – шестирядний ячмінь.
Форми з довгими остюками (1, 5, 9)
Форми з короткими остюками (2, 6, 10)
Здуті форми (3, 7, 11)
Форми без остюків (4, 8, 12)
виникли близько 33 % культурних рослин, наприклад рис, лимон, огірок, манго. На Східноазійський центр припадає 20 % культурних рослин: просо, гречка, соя, редька, яблуня, груша тощо. Із Південно-західноазійського центру походять морква, абрикос, бавовник, виноград тощо. Цукровий буряк, капуста, селера, кріп, гірчиця й олива виникли в Середземноморському центрі. З Абісінського центру походять тверда пшениця, кавун, кавове дерево та зернове сорго. З Центральноамериканського центру походять гарбуз, какао, соняшник, квасоля та кукурудза. Картопля, томати, ананас, арахіс та хінне дерево – з Південноамериканського центру. Учення про центри різноманітності та походження культурних рослин дало змогу встановити, що для різних видів культурних рослин є свої центри різноманітності, де виявлено найбільшу
і районами їхнього походження. Виявлення
можна шукати різноманітний вихідний матеріал для селекційної роботи. Райони одомашнення та походження порід свійських тварин
давніми центрами землеробства, однак
ських тварин значно
3.
4.
5.
Сучасна
напрями § 44.
Що таке ферменти, вітаміни, гормони та інтерферони?
Що таке трансгенні організми?
Нинішнє століття називають «золотим віком біології». Це стосується й одного з її напрямів, що розвивається високими темпами, – біотехнології.
Поняття біотехнології. Як уже було відзначено, людина здавна навчилася використовувати хімічні перетворення, що відбуваються в живих організмах, для своїх потреб – хлібопечення, сироваріння, пивоваріння, виноробства. Тому можна стверджувати, що біотехнології виникли й застосовувалися досить давно. ! Біотехнологія (від грец. bios – життя, techne – мистецтво, logos –вчення) – наука про використання біологічних об’єктів і хіміко-біологічних процесів у промисловому виробництві, сільському господарстві, енергетиці й медицині. Науковий термін
хімії, мікробіології, молекулярній
що вможливлюють використання властивостей біооб’єктів з визначеною метою. Об’єктами
бути молекули (ферменти, вітаміни, амінокислоти, білки), неклітинні форми життя (віруси), одноклітинні організми (бактерії, дріжджі) та
клітинні організми (рис. 208).
Рис.
логій добування
промисловостях. Напрями сучасної біотехнології. Біотехнологія невпинно розвивається, особливо її нові напрями: генетична інженерія, клітинна (тканинна) інженерія, інженерна ензимологія й імунологічна біотехнологія. Науковим відкриттям, що вможливило розвиток цих напрямів, стало розкриття таємниці будови молекули ДНК (рис. 209). Генетична інженерія – галузь біотехнології, завданням якої є конструювання генетичних структур з метою створення організмів з новою генетичною програмою. На початковому етапі науковці отримують
матеріал шляхом штучного синтезу або виділення природних
використовуючи ці гени, створюють рекомбінантну молекулу на ДНК, яку вводять у клітину-реципієнта. Клітинна (тканинна) інженерія – галузь біотехнології, завданням якої є конструювання клітин
гібридизації та реконструкції.
що базується на використанні ферментів
Що таке селекція?
Якими є результати її проведення?
Розвиток біології дав людству більш
інструменти для
нових форм, ніж традиційна селекція, яка ґрунтується на штучному доборі. Поняття генетично модифікованих організмів. Методи генетичної інженерії вможливили створення генетично модифікованих організмів. ! Генетично модифіковані організми (ГМО) – це організми, генотип яких було змінено за допомогою методів генетичної інженерії, тобто внесення скерованих змін у структуру ДНК. Така зміна може полягати в інактивації певних генів, уключенні в геном генів інших видів тощо. В останньому випадку отримані організми називають трансгенними. Скерованість унесених змін є ключовою відмінністю генетичної інженерії від традиційної селекції або штучного мутагенезу. Найпоширенішим методом генетичної інженерії є перенесення спадкової інформації
допомогою векторів,
інсуліну з підшлункових залоз тварин. Генетично модифіковані мікроорганізми слугують для отримання антитіл, гормонів, антибіотиків, вітамінів тощо. ГМО та селекція. Першими генетично модифікованими рослинами, дозволеними для вживання в їжу, були FlavrSavr (Flavour Saver) томати. Нині трансгенні рослини вирощують у 25 країнах, де проживає 3,6 млрд, або 54 % світового населення. Найбільше вирощують генетично модифіковану сою, кукурудзу та бавовну. Основними напрямами генетичної модифікації культурних рослин є вироблення стійкості до гербіцидів і паразитів, збільшення врожайності, підвищення вмісту корисних сполук (рис. 211). Одним з поширених варіантів генетичної модифікації рослин є введення в
гену стійкості до гербіциду гліфосату. На оброблених ним полях залишаються лише стійкі культурні генетично модифіковані рослини. Генетично модифікованих тварин також уживають у їжу. Першою схваленою ГМО розробкою був лосось AquAdvantage. Основою його був атлантичний лосось, якому замінили ген-регулятор гормону росту. Це призвело до того, що риба стала рости протягом усього року, а не лише навесні та
роді. Унаслідок цього
Що таке здоров’я?
Які основні шляхи його підтримки та зміцнення?
Ви пам’ятаєте, що розвиток медицини тісно пов’язаний з успіхами біологічної науки. Найактивніша взаємодія між біологією та медициною розпочалася наприкінці ХIХ – на початку ХХ століття. Значення досягнень біології для розвитку медицини. Розвиток мікроскопічної техніки дозволив вивчити будову організму людини на тканинному та клітинному рівнях, визначити закономірності ембріонального розвитку людини тощо. Відкриття бактерій і дещо пізніше вірусів дало розуміння причин розвитку інфекційних захворювань і започаткувало науково обґрунтований пошук шляхів боротьби з ними. Виникнення генетики дало можливість зрозуміти причини спадкових захворювань. Розвиток біохімії дозволив з’ясувати основні шляхи
з найважливіших для медицини біологічних відкриттів
тибіотиків. Сучасна
функціонуванні організму
Сконструйований вірус несе ген mCherry – кодований ним білок має здатність до флуоресценції (поглинає світло однієї частоти та випромінює світло іншої частоти). Ін’єкцію вірусу роблять у певні ділянки організму (тут –головний мозок). Унаслідок активації вірусу клітини починають виробляти білок mCherry, кількість якого можна виміряти за інтенсивністю флуоресценції. Особливістю сконструйованого вірусу є те, що він активується лише в нервових клітинах певного типу. Таким чином, інтенсивність

цукровий діабет, знижена кількість гемоглобіну – анемія) тощо. Гістологічний аналіз дозволяє виявити порушення в будові тканин організму внаслідок уроджених вад або ж ідентифікувати ракові пухлини. Цитологічні методи вможливлюють виявлення спадкових захворювань, наприклад пов’язаних зі зміною числа хромосом (синдром Дауна). Мікробіологічні методи дозволяють виділити з організму й ідентифікувати збудників деяких інфекційних хвороб. Розвиток молекулярної біології збагатив медицину низкою сучасних методик. Так, полімеразна ланцюгова реакція (ПЛР) забезпечує копіювання молекул ДНК лабораторного зразка, щоб далі мати можливість аналізувати їх іншими методами. За допомогою ПЛР можна точно (ідентифікуючи специфічні гени) визначити наявність вірусів чи інших збудників
ни. У 2013 році було вперше вирощено зі стовбурових клітин цілі
доступних для пересаджування органів людини. Нещодавно опубліковано дослідження, автори якого генетично модифікували ембріони свиней. Головним методом редагування геному була ферментативна система CRISPR/Cas9 (рис. 214). Учені одночасно модифікували понад 60 генів, що містили послідовності ендогенних ретровірусів. Такі послідовності трапляються в геномі практично всіх ссавців і є наслідками
боротьби видів з вірусними інфекціями:
в разі трансплантації органів в організм іншого виду (ксенотрансплантація). Свині є потенційними джерелами донорських органів, а проведене дослідження сприятиме посиленню безпеки такої пересадки. Зважаючи на значущість цієї роботи, їй було присвячено обкладинку престижного наукового
Рис. 214. Схема технології редагування геному
ферментативної системи
(рис. 215).
(4). Цей процес триває 2–8 тижнів. Відтак генно модифіковані лімфоцити вводять до організму хворої людини (5), де вони розпізнають за допомогою рецепторів і знищують ракові клітини. Користь чи небезпека. Сучасні молекулярно-біологічні технології дозволяють проводити практично будь-яку генну модифікацію будь-яких клітин. Головною проблемою є знайти, яку ділянку ДНК яким чином змінити. Наука накопичила чимало відомостей стосовно генних хвороб
уразливість
проблему хвороби чи схильності до неї. У технічному
методику з описаною раніше технологією імунотерапії раку гальмуванням негативної імунної регуляції. Що спільного, а що відмінного вони мають?
Що таке клітинний цикл, диференціація
біотехнології є клітинна (тканинна) інженерія. Певно, найбільш
успішне клонування тварин, уперше здійснене у
цей лабораторний метод став
сполуки, які можуть бути потенційними ліками. Направлена генетична
роль певних генів та їх регуляцію у функціонуванні клітини. Культивування ліній клітин, отриманих з ракових пухлин, дає
ня особливостей онкогенної трансформації
боротьби із захворюванням. Також клітинні культури є
інфікування тварин або рослин, що є
Такі структури є
нирок, кишечника, головного мозку, печінки, легень тощо (рис. 218). Важливим напрямком практичного застосування тканинної інженерії є виготовлення складників організму для заміни ушкоджених (зокрема трансплантації органів). Ви пам’ятаєте, що процес розвитку організму та його частин пов’язаний із функціональною спеціалізацією клітин – диференціацією. У багатьох випадках зрілі клітини втрачають здатність до поділу, що робить неможливим їхнє культивування в штучному середовищі. Вирішенню цієї проблеми сприяло відкриття механізму перепрограмування дорослих клітин. За допомогою спеціалізованих регуляторних сполук (факторів росту) зріла клітина, наприклад фібробласт сполучної тканини, повертається до менш диференційованого стану – стає стовбуровою клітиною (рис. 219). Надалі за допомогою інших регуляторних сполук можна запустити її розвиток у
напрямку – вирощувати нервові, епітеліальні або інші клітини. Для створення
Поняття про
захист
Що таке інфекційні захворювання? Які існують шляхи передавання інфекційних захворювань?
Як вам уже відомо, на організми впливають поміж інших чинників і біотичні. Такий вплив зумовлений
організмами й може бути небезпечним. Небезпека – поняття, що об’єднує процеси чи явища, здатні за певних умов погіршити або внеможливити функціонування та розвиток
Біологічна небезпека. Знання біологічних небезпек необхідне
хисту організму. ! Біологічна
людини, тварин або рослин унаслідок прямого впливу «інфекційного агенту» або непрямого впливу через руйнацію навколишнього середовища. Небезпеку для життя та здоров’я людини
становити як організми (бактерії, гриби, рослини, тварини), так і продукти їхньої життєдіяльності (соки, смоли, отрути, токсини, алкалоїди тощо) (рис. 220). Наслідком біологічних небезпек є хвороби, травми різного ступеня тяжкості, зокрема й летальні випадки. Окремої уваги заслуговують віруси – мікроскопічні, неклітинні форми, які є внутрішньоклітинними паразитами та збудниками багатьох тяжких захворювань (віспа, грип, енцефаліт, кір, гепатит, СНІД тощо). Небезпечними збудниками інфекційних захворювань є
можуть бути особливо небезпечними.
Рис. 220. Характеристика дії отруйних речовин
Блекота чорнаРослини
шиї, збуджений стан, судоми рук і ніг, галюцинації, слинотеча, а згодом сухість у роті Поганка блідаГриби Біль під грудьми, постійне блювання, згущення крові, судоми, летальні випадки
Тарантул
Тварини.
Павукоподібні
Іксодові кліщіТварини. Павукоподібні
Сильні больові відчуття, головний біль, слабкість, порушення свідомості, судоми, тахікардія, підвищення тиску, летальні випадки
Укуси, почервоніння, свербіж, стан загального отруєння. Імовірність зараження енцефалітом Бджола медоноснаТварини. Комахи Алергічні реакції, анафілактичний шок, запалення, больові відчуття, летальні випадки
Хвостокол звичайнийТварини. Хрящові риби
Уколи, слабкість,
1. Потенційно небезпечні
паличка), які не викликають хвороб у здорової людини. Базові вимоги захисту – рукавички, захист обличчя.
2. Агенти, що являють помірну небезпеку для людини та середовища, – віруси гепатиту А, В, С, ВІЛ, золотистий стафілокок тощо. Робота з ними вимагає спеціального навчання персоналу, обмеженого доступу в лабораторії, підвищених вимог до стерилізації забруднених предметів.
3. Інфекційні агенти, що викликають смертельні захворювання, що легко поширюються повітрям, – збудник туберкульозу, віруси жовтої гарячки, лихоманки Західного Нілу тощо. Співробітники, окрім спеціального навчання, проходять відповідну імунізацію (за можливості), використовують захисний костюм, переміщення людей та обладнання в та
лабораторій суворо контролюють для запобігання дії чинників.
4. Особливо небезпечні агенти, що викликають хвороби, проти яких відсутні ефективні вакцини або способи
або питної води, другий – інфікування переносників (комарі, блохи), які заражають
рення аерозольних хмар, які респіраторно
населення та здійснюють зараження місцевості. Біологічний захист. Випадки застосування біологічних засобів і переносників хвороб можна встановити, виявивши аерозольну хмару, залишки спеціальних контейнерів, велику кількість
для цієї місцевості. У такому разі треба використати засоби біологічного захисту. ! Біологічний захист
явлення та локалізацію чинників біологічного зараження,
територій.
витку.
знезаражування осередку
ємствами, установами
дарювання.
2.
3.